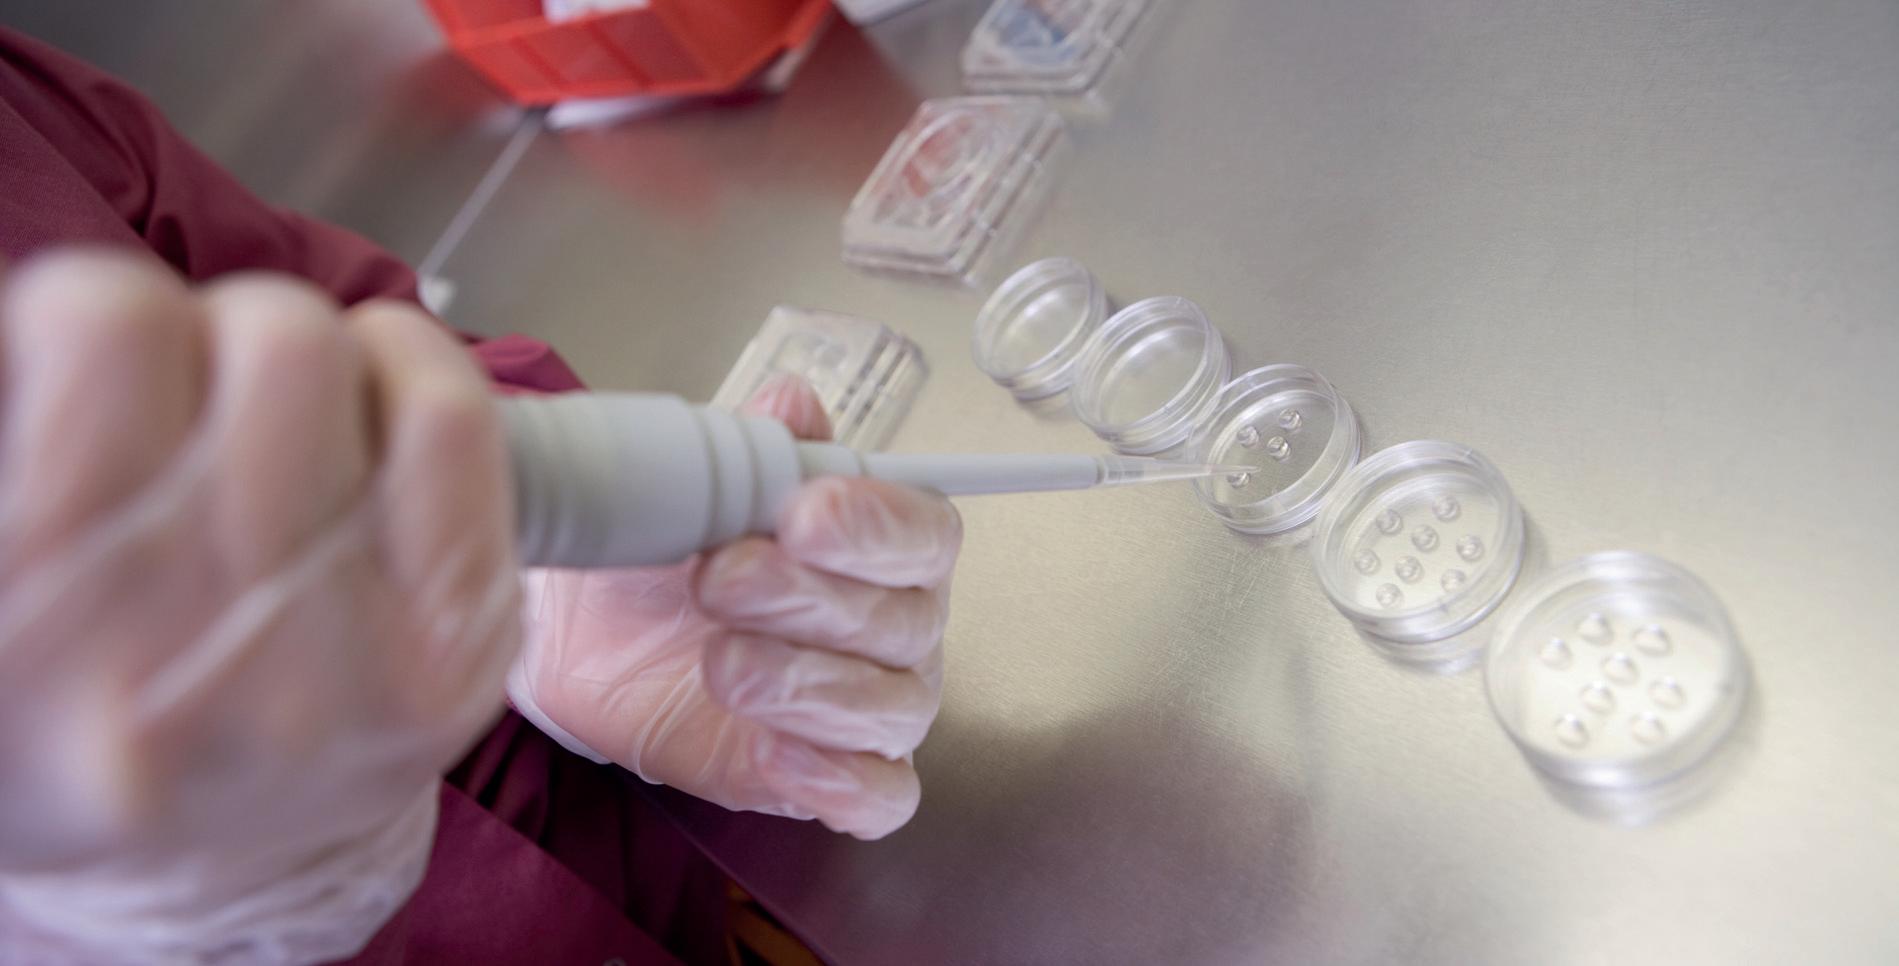

Farmasiliv

Jorunn Berland er ny YS-leder:






![]()

Jorunn Berland er ny YS-leder:






Så er vi kommet i havn med årets lønnsoppgjør i Virke-området.
Lønnsoppgjøret i Virke-området omfatter Apokjeden, Boots og ikke-kjedeeide apotek. I år var oppgjøret samordnet, og det betyr at Farmasiforbundet var et av flere YS-forbund som forhandlet i samme oppgjør. I Spekter-oppgjøret, som omfatter våre medlemmer i Vitus og sykehusapotek, er de sentrale, innledende forhandlingene også vel i havn.
I Virke-oppgjøret ble de lokale forhandlingene tatt med i det sentrale oppgjøret. Jeg mener vi er på rett vei, og må se oss fornøyd med det som ble sluttresultatet. Vi fikk også en protokolltilførsel som sier at vi skal sette ned utvalg sentralt og lokalt for å se på tariffbestemmelsen «lokale forhandlinger» med frist 1.1.2014, for på den måten å få en diskusjon på om vi kan fortsette å ha lokale forhandlinger. Jeg mener vi ikke kan fortsette slik vi har hatt det tidligere, der de lokale forhandlingene i realiteten ikke har vært reelle.
«Jeg er stolt av å være forbundsleder for alle apotekteknikere som jeg vet gjør en kjempejobb på apotekene.»

med frist 1 1 2014, for Jeg mener vi ikke en ikke har vært


Lønnsoppgjøret i år er en begynnelse, og jeg ser frem til fortsettelsen neste år.

Farmasiforbundet har åpnet en ny arena for debatt på farmasiforbundet.no, kalt «Meninger».
Målet er enda mer dialog – hører vi fra deg?
kerne er n
Jeg mener lønnen skal gjenspeile den jobben vi gjør på apotekene. Apotekteknikerne er tross alt de som fronter apoteket og gir den største inntjeningen til kjedene. Jeg er stolt av å være forbundsleder for alle apotekteknikere som jeg vet gjør en kjempejobb på apotekene, og skal gjøre det jeg kan for at apotekteknikere får en lønn de fortjener og kan leve av.


































Følg oss på Facebook for nyheter og interessante diskusjoner! facebook.com/nullhull


Alle Fluxprodukter er uten alkohol og parabener












Flux Original Fluorskyll inneholder mye fluor, 0,2% NaF. Ved å bruke Flux morgen og kveld vil det gi en god munnhygiene som samtidig beskytter mot karies. En smart doseringspumpe gir en perfekt dosering hver gang, som gir sterke tenner og et vakkert smil.
Flux Sensitiv har en mildere smak og inneholder pleiende Aloe Vera. Flux Sensitiv har samme høye fluorinnhold som Flux Original, 0,2% NaF. Fluxfamilien består i tillegg av Tannkrem, Flux Klorhexidin (0,12% klorhexidin og 0,2% NaF) og for barn finnes Flux Junior. For mer informasjon besøk gjerne www.fluxfluor.no











Le, pust og spis. Sterkere enn i går.

- For et skue! sa leder i Region øst, Torhild Sandboe Sauro, da hun så utover forsamlingen under åpningen av Apotekteknikerdagen 2013. I Nydalen i Oslo var rundt 150 glade medlemmer samlet denne søndagen i mars.
Tekst og foto: Vetle Daler
- Dere fortjener en dag der dere lener dere tilbake, uten å ta ansvar for å hjelpe til. Klarer dere det? spurte psykolog, bedriftsrådgiver og spaltist Karen Kollien Nygaard, som var hyret inn for å lose deltakerne gjennom programmet for dagen. På agendaen sto blant annet foredrag med Lillian Tiller om holdninger til arbeidsgiver, arbeidsplass og kollegaer; forbundsleder Irene Hope om Farmasiforbundets hovedsatsingsområder; fagsjef Berit Regland om forbundets satsing på fag og utdanning; nestleder Bodil Røkke Havig om apotekteknikere i framtida, og Apotekforeningens fagdirektør
Per Kristian Faksvåg om Apotekforeningens satsingsområder.
- Jeg vil gratulere Region øst med et fantastisk arrangement. jeg er stolt av å være forbundsleder i et forbund med så mange dyktige apotekteknikere, sa forbundsleder Irene Hope da dagen gikk mot slutten.
- Som psykolog er jeg vant til å stille diagnoser – og min diagnose på dere her i dag, er at dere har hatt 360 grader tilstedeværelse. Og dere har brukt en hel søndag på dette. Jeg er dødelig imponert, avsluttet Karen Kollien Nygaard.

Tolv ulike leverandører demonstrerte produktene sine utenfor konferansesalen, og fikk mange kloke og relevante spørsmål.












- Jeg brenner for at yrkesgruppa vår skal bli mer synlig. Det er på tide å slå et slag for yrkesstoltheten, sa nestleder Bodil Røkke Havig.



Smil og latter preget Apotekteknikerdagen 2013.








- Det gleder meg at dere fokuserer på faget. Dere er veldig viktige for å holde apoteknorge i gang, sa Apotekforeningens fagdirektør Per Kristian Faksvåg.


Tapas-buffeten falt i smak blant deltakerne på Apotekteknikerdagen 2013.

Farmasiforbundets medlemmer i Apotek 1, Boots og ikke-kjedeeide apotek får et samlet lønnstillegg på 5 kroner og 65 øre pr time. Det ble resultatet av forhandlingene mellom YS og arbeidsgiverforeningen Virke i dag. Det blir ikke gjennomført kjedevise forhandlinger i dette oppgjøret.
Farmasiforbundets medlemmer er innvilget et generelt tillegg på 0,75 kroner, samt et lavtlønnstillegg på 1 krone og 40 øre – totalt kroner 2 kroner og 15 øre. Dette er i tråd med føringene fra frontfagsoppgjøret. Videre er Farmasiforbundets medlemmer innvilget et særskilt utjevningstillegg på kroner 3 kroner og 50 øre. Samlet gir dette Farmasiforbundets medlemmer i Virkeområdet et tillegg på kroner 5 kroner og 65 øre, som til sammen utgjør kr. 10 577,- pr år. I tillegg ble partene enige om at det skal gjennomføres et arbeid både sentralt og lokalt for å se på lønnsdannelsen, der

YS og arbeidsgiverforeningen Spekter har i de innledende, sentrale forhandlingene blitt enige om et kronetillegg på 1 463,- for alle arbeidstakere. Arbeidstakere med årsinntekt på mindre enn 365.670 kroner får et tillegg på totalt 4 193 kroner. Farmasiforbundets medlemmer i Vitusapotek og sykehusapotek er omfattet av disse forhandlingene. For sykehusapotekenes del fastsettes imidlertid hele lønnstillegget i de foretaksvise forhandlingene.
- Tilleggene er i overensstemmelse med resultatet fra meklingen mellom YS og NHO tidligere denne uka, og også i samsvar med vårt krav, opplyser Farmasiforbundets forhandlingsleder Bodil Røkke Havig. Nå skal oppgjøret videre i lokale forhandlinger. For Farmasiforbundets medlemmer i Vitus betyr dette at det nå vil bli gjennomført forhandlinger på kjedenivå, og eventuelle tillegg her vil komme på toppen av det sentrale tillegget som ble framforhandlet mellom YS og Spekter. Vi vil komme tilbake med mer informasjon knyttet til denne kjeden på et senere tidspunkt.
målet for arbeidet er at lønnsdannelsen lokalt og sentralt skal gjennomføres i samsvar tariffavtalens bestemmelser.
- Vi har et lønnsmessig etterslep, og er derfor tilfreds med at arbeidsgiver ser nødvendigheten av å gi våre medlemmer et særskilt tillegg, sier forbundsleder Irene Hope.
- Vi er også fornøyd med at det nå nedsettes et eget utvalgsarbeid for å gjennomgå lønnsdannelsen, og fordelingen av lokale og sentrale forhandlinger innenfor dette tariffområdet. Vi har også akseptert at det ikke vil bli gjennomført lokale forhandlinger innenfor vårt tariffområde i mellomoppgjøret 2013, sier forbundslederen.
Lurer du på hvordan lønnsoppgjøret foregår? Eller hva som er forskjellen mellom sentrale og lokale forhandlinger?
Alt du trenger å vite finner du på www.farmasiforbundet.no


Når det gjelder sykehusapotek, fastsettes hele lønnstillegget i de foretaksvise forhandlingene. Det vil si at resultatet fra de sentrale forhandlingene blir en del av de lokale forhandlingene på sykehusapotekforetaksnivå. Vi vil avvente lokale forhandlinger her, til etter at oppgjøret i offentlig sektor er gjennomført, og etter at vi ser resultatene i de andre forbundenes såkalte A2forhandlinger. Også her vil vi komme tilbake med mer informasjon på et senere tidspunkt.
Forhandlingene mellom YS Spekter og Arbeidsgiverforeningen Spekter omfatter om lag 15 000 medlemmer i følgende YS-forbund: Bibliotekarforbundet, Delta, DNMF, Farmasiforbundet, Finansforbundet, NBFF, Negotia, Parat, STAFO og Yrkestrafikkforbundet.



BINDER BAKTERIENE
Sorbact er et bakteriebindende plaster som reduserer risikoen for infeksjon og bedre tilheling av sår. Filmbandasjen er vanntett, med god pusteevne.
Sorbact gir en spesielt gunstig beskyttelse i miljøer med økt risiko for infeksjon – på reiser, barnehagen og ulike uteaktiviteter.
Nå i salg på utvalgte apotek.
Hun er leder for 226.000 YS-medlemmer. Selv vil hun være Jorunn, bare Jorunn, og den samme uansett hvem hun snakker med.
Tekst: Gunhild Lervåg og Vetle Daler Foto: Erik Norrud
Jorunn Berland (57) sitter ytterst på stolen, klar til å gå til aksjon. Så er hun også en handlingens kvinne. I hvert fall er det slik kolleger beskriver henne. De sier hun er handlekraftig – og da sikter de ikke til at hun har «svart belte i shopping», som hun selv sier. Første dag på jobb etter at hun ble valgt til YS-leder, sørget hun for å ommøblere kontoret. Mens andre ommøblerer for å få det penere, gjør Jorunn det for at det skal bli mer effektivt. Gardinene mot gangen måtte bort, skrivebordet ble flyttet slik at hun ble synlig og selv ser hva som rører seg i niende etasje i YS-huset i Oslo. - Jeg vil ikke sitte i skjul, og er tilhenger av å ha åpen dør. Jeg ønsker å framstå som åpen person, og ønsker mange innspill fra mine kollegaer. Det er bedre med ett innspill for mye enn ett for lite, sier hun.
Nyvalgt leder
bare inn i Finansforbundet (den gang Norske bankfunksjonærers forbund), fordi medlemskap var inngangsbilletten til fester. - Alle de andre skulle på fest med lokallaget før jul, og jeg ville også være med, forteller Jorunn Berland, med en liten latter. Hun så ingen andre grunner til å fagorganisere seg.
– Nei, hvorfor skulle jeg det? Det var ingenting fra min oppvekst som tilsa at jeg skulle organisere meg. Pappa var organisert, men det var lite snakk om det hjemme, forteller Jorunn. Noen år senere ble hun oppringt av en kollega som ville overtale henne til å bli tillitsvalgt. Det var hun ikke interessert i.
«Når kolleger skal beskrive Jorunn Berland, dukker to ord fort opp: Raus og krevende»
- Men etter to og en halv time på telefonen, sa jeg ja, jeg orket ikke snakke mer. Jeg tenkte at jeg kunne være vara i en periode, og så hadde jeg gjort mitt.
Trives med makt
Snur hun hodet den andre veien, ser hun mot Barcode-rekka i Bjørvika. Den huser hennes gamle arbeidsplass, Finansforbundet. I nesten ti år var hun forbundsleder der. Helt til Tore Eugen Kvalheim en februardag i år overraskende forlot sjefsstolen for å bli direktør i arbeidsgiverforeningen Spekter. Jorunn var nestleder i YS og ble plutselig fungerende leder. Ny YS-leder ønsket hun i utgangspunktet ikke å bli. Den som stiger til topps i YS, brenner broene til forbundene de kommer fra siden dette er et heltidsverv. – Jeg spurte meg selv: Hva er det verste som kan skje? Det verste som kan skje er at jeg ikke blir gjenvalgt, og det er ikke verdens undergang. Svaret gjorde at jeg valgte å stille til valg, forteller Jorunn. I begynnelsen av mars sto hun med armene fulle av blomster og var nyvalgt YS-leder.
Inngangsbillett til fest
Da hun ble tillitsvalgt i Bergen bank for 30 år siden, hadde hun ikke lyst på vervet i det hele tatt. Hun meldte seg egentlig
Slik gikk det ikke. Snøballen begynte å rulle. Det har den gjort i flere tiår, og den har ikke smeltet ennå. Den har bare blitt større og større, ja så stor at den har dyttet henne til topps og gjort henne til en mektig leder for 226.000 medlemmer.
- Jeg er klar over at jeg har mye makt. Makt var ikke motivasjonen for å bli leder, men jeg trives med makt, jeg liker å påvirke og å være med på å bestemme, sier Jorunn Berland, og fortsetter: - Men jeg mener jeg er bevisst på å forvalte makten til medlemmenes beste. Det handler om å bruke makten på en positiv måte. Makten jeg har skal jeg ikke bruke for meg selv, men for dem jeg opptrer på vegne av.
Riktig påkledd
Når kolleger skal beskrive Jorunn Berland, dukker to ord fort opp: Raus og krevende. Den beskrivelsen kjenner hun seg igjen i.
- Det er hyggelig å bli omtalt som raus, men jeg driver ikke

«Det YS leverer, skal være preget av kvalitet»

Samarbeidspartnere: Jorunn Berland omtaler konsekvent arbeidsgiversida som «samarbeidspartnere». Her sammen med KS-direktør Sigrun Vågeng.

Trives med makt: - Jeg liker å påvirke og å være med på å bestemme, sier Jorunn Berland, her på et møte i egjeringens representasjonsbolig i Parkveien i Oslo.
noe sololøp. Jeg henter inn kompetanse hos andre. Jeg gir ros og oppmerksomhet når jeg ser at andre strekker seg for å levere til meg.
Gjennom posisjonen sin mottar Berland gaver. Dem deler hun med andre som har bidratt. De som har jobbet med henne, vet at hun krever mye av dem.
- Jeg forventer å få ting til avtalt tid. Det skal være av god kvalitet, og de skal ha en god grunn til ikke å levere til fristen, understreker hun.
- Jeg har ingen problemer med å stå på scenen, men da må de rundt meg sørge for at jeg er «riktig påkledd». Alle fagpersonene rundt meg må sørge for at jeg har nok kunnskap, sier hun, og fortsetter: - Det YS leverer, skal være preget av kvalitet. Vi skal tørre å være en annerledes hovedorganisasjon. Vi skal tørre å tenke annerledes, og gjøre uventede ting. Utsagn som «sånn har vi alltid gjort det» og
«det har vi prøvd før» er det verste jeg vet. Det vi gjør, gjør vi fordi det er riktig, ikke fordi vi alltid har gjort det sånn.
Ingen autoritetsskrekk
Noe annet som kjennetegner Jorunn Berland, er at hun bruker et enkelt språk. Hun bruker det samme språket samme hvem hun snakker med. Folk er folk uansett, og Jorunn er Jorunn, samme hvem hun snakker med. I hvert fall er det slik hun selv ser på det.
«Vi
skal tørre å være en annerledes hovedorganisasjon»
– Jeg tenker at det illustrerer nærhet at man omtaler hverandre med fornavn, sier hun. I sitt verv på toppen av YS møter hun stadig både statsråder og statsminister, og har ingen problemer med å hilse på andre maktmennesker. – Jeg har ingen autoritetsskrekk, da hadde dette ikke gått bra, sier hun.


På den andre siden er Jorunn svært opptatt av å ha tett kontakt både med medlemmer og kolleger i YS-systemet.
– Her om dagen møtte jeg noen som ble overrasket over å se meg i kantina. «Skal YS-lederen spise i kantina?» var spørsmålet. Ja, det skal YS-lederen gjøre! Jeg prøver å sette meg på forskjellige steder, og er bevisst på hvem som «eier» situasjonen eller møtet.
Byen er Bergen
De siste ti årene har Jorunn Berland ukependlet fra Bergen til Oslo. I Bergen har hun samboeren Arnt Hugo. Jorunn har ikke barn selv, men er sterkt knyttet til tantebarna sine. De beskriver henne som «snill, men streng».
- Jeg er bergenser på min hals. Derfor ukependler jeg. Byen er Bergen og laget er Brann, slår Jorunn fast.
«Jeg har etter hvert blitt en rimelig gal supporter»
Fotballinteressen hennes gikk fra null til hundre over natta. En søndag slengte hun seg med kolleger som skulle på fotballkamp. Dermed var det gjort. Siden midten av 80-tallet har hun vært på alle cupfinaler bortsett fra to. I år har hun abonnement på alle landskamper.
- Jeg lar meg lett rive med. Jeg var egentlig ikke interessert i fotball i det hele tatt, men har etter hvert blitt en rimelig gal supporter, smiler hun.
Omtrent som hennes interesse for fagforeningsarbeid, med andre ord.
Navn: Jorunn Berland (57)
Stilling: Leder i YS
Familie: Samboer
Bosted: Bergen/Oslo
Bakgrunn: Bankfunksjonær, mangeårig tillitsvalgt i bank og forsikring, leder i Finansforbundet 20032013
Helgen 9. og 10. mars møttes en glad gjeng tillitsvalgte til tillitsvalgtsamling og årsmøte i Trondheim.
På agendaen:
• Organisasjonsstruktur, hvordan spiller vi hverandre gode?
• Arbeidsdeling, hvem gjør hva?
• Tariffoppgjøret
• Konfliktberedskap
• Utviklingsprogram for tillitsvalgte
• Fusjon - hvor står vi nå?
• Utviklingen av organisasjonen og apotekfaget
• Årsmøte
Vi takker alle sammen for ei trivelig helg på Rica Nidelven!
Målfrid Flåt Gresdahl
Les hele referatet og årsmøteprotokollen på farmasiforbundet.no


1100 jenter i alderen 10 til 14 år fikk p-piller i fjor, ifølge ferske tall fra reseptregisteret.
Fastlege Eli Øvstedal ved Flatåsen legesenter i Trondheim forteller at mange av jentene som får hormonell prevensjon i så ung alder, ofte får det fordi de har store mensturasjonssmerter. For flertallet er sex helt utelukket, mener hun. Øvstedal bekrefter at ungdom mellom 12 og 14 år kan få resept uten at foreldrene vet om det, men presiserer at det skal være gode grunner til at ungdom får prevensjon uten at foreldrene vet det. Hun ikke dette er noe stort problem - hennes oppfatning er at de fleste unge jentene uansett har med moren sin til legen. Helsesøstre kan ikke skrive ut p-pilleresept til jenter under 16 år uten at en lege er konsultert.
- Det er vanskelig å gi noe eksakt tall på hvor mange ungdomsskoleelever som bruker p-piller, men det er snakk om en liten prosentandel. Og det er ikke så enkelt at de bare kan komme og si at de vil ha p-piller, understreker hun.
(aftenposten.no)
Farmasiforbundet er bekymret for utviklingen innen legemidler utenom apotek (LUA), og ber Legemiddelverket om å gjennomføre en undersøkelse av LUA-ordningen.
- Farmasiforbundet har ved flere anledninger ytret bekymring og skepsis til omsetning av legemidler utenom apotek. Samtidig anerkjenner vi et visst behov for enklere tilgang til legemidler. Vår generelle bekymring er at så mye legemidler omsettes av ufaglærte, og at den skriftlige informasjonen ikke er noen forsikring mot feilbruk, skriver forbundsleder Irene Hope i en høringsuttalelse til Legemiddelverket.
- Farmasiforbundet vil sette pris på om Legemiddelverket gjennomfører, eller ber Mattilsynet foreta, en undersøkelse av LUA-ordningen. Spesielt med tanke på om Mattilsynet har nok ressurser og kompetanse til å utføre tilstrekkelig tilsyn, heter det i høringsuttalelsen.

I forkant av lønnsoppgjøret var 40 engasjerte tillitsvalgte fra utvalgte Apotek 1- og Boots-apotek samlet i Oslo for konfliktberedskapskurs. Det ble ikke streik denne gangen, men Farmasiforbundet er nå bedre rustet enn noensinne når det gjelder å være klare til å ta en konflikt i framtidige lønns- og tariffoppgjør.
- Vi er glad for at Stortinget enstemmig har bedt Regjeringen om å lage en ny stortingsmelding om legemiddelpolitikken. Riktig bruk av legemidler bør være det viktigste i en slik melding, sier adm. dir. Per T. Lund i Apotekforeningen.
Stortinget vedtok nylig enstemmig et forslag om å utarbeide en ny stortingsmelding med en helhetlig gjennomgang av legemiddelpolitikken. Det er åtte år siden sist det ble gjort en tilsvarende gjennomgang.
- Feil legemiddelbruk er erkjent som et stort problem. Vi ser frem til å bidra til Helse- og omsorgsdepartementets arbeid med en legemiddelmelding, der riktig legemiddelbruk bør være et hovedtema, sier Lund.
(apotek.no)
I fjor ble det omsatt såkalt trekant-medisin for 700 millioner kroner. Én million nordmenn bruker slike medisiner, og altfor mange kjører bil i pillerus.
Den røde varseltrekanten på pilleboksene viser at man skal være forsiktig med å kjøre bil. Men det er det mange som ikke vet, eller de tenker ikke over farene.
– 45 prosent av de som omkommer i trafikken er påvirket. De fleste av legemidler utskrevet av lege. De kjører i pillerus, og da er reaksjonsevnen mye dårligere, sier rådgiver Jens Christian Bechensten hos Fylkesmannen i Oppland.
(nrk.no)
Oslo Kongressenter, Folkets Hus, 21.–22. august
To intensive dager, hvor følgende temaer står sentralt:
• Den debatterte og omfattende samhandlingsreformen
• Primærforebygging av diabetes type 2
• Nytt om senkomplikasjoner ved diabetes type 1
• HbA1c som diagnostiseringsverktøy
• Avslutningsvis spennende nyheter fra forskningen
Nasjonalt Diabetesforum 2013 er godkjent av Den norske legeforening for allmennmedisin og pediatri med 17 timer, og indremedisin med 12 timer.
Nasjonalt Diabetesforum er også godkjent med 17 timer for følgende helsepersonellgrupper: Sykepleiere, psykologer, bioingeniører, legemedarbeidere/ helsesekretærer, hjelpepleiere/omsorgsarbeidere, helsefagarbeidere, fotterapeuter og apotekteknikere.
Program og påmelding: www.diabetes.no/diabetesforum2013
For spørsmål vedr. konferansen kontakt organisasjonskonsulent Liv Nordby tlf. 464 46 783 eller liv.nordby@diabetes.no
www.diabetes.no
200 000 nordmenn har kjøpt medisiner på nett. Nettkjøp kan utgjøre en helsefare for kjøperen. For å informere om farene, lanserte Legemiddelverket, Tollvesenet og Legemiddelindustrien i november 2012 en nettside som utgir seg for å være et nettapotek.
Anslagsvis 90 prosent av ”apotekene” som selger medisiner på internett er ikke lovlige, og det er ingen garanti for at varene som selges er ekte. For å sette fokus på dette, lanserte Legemiddelverket, Tollvesenet og Legemiddelindustrien “www.pharmacyforyou.no”. Hensikten med «nettapoteket» var å se hvor mange som fant siden, hvilke produkter de var ute etter, samt lede de besøkende til informasjon om faren ved kjøp av medisiner på nett.
- «Nettapoteket» vårt inneholder bare to sider, en inngangsside med annonser for medisiner og en bakenforliggende informasjonsside, forteller Dag Jordbru, avdelingsdirektør i Avdeling for legemiddelinformasjon. - På informasjonssiden har Legemiddelverket, Tollvesenet og LMI sammen laget kortfattet informasjon med advarsel til de som vurderer å handle medisiner og/eller kosttilskudd på nettet, forklarer han.
I løpet av fire uker var rundt 1400 personer innom siden. Statistikken viser at de besøkende klikket på medisiner for slanking, depresjon, håravfall, potens, influensa og sovemedisin. Den viser også hvor lenge brukerne ble på siden.
å


- At brukerne valgte å bli i snitt 35 sekunder på informasjonssiden tyder på at de leste informasjonen vi har lagt ut. 62 prosent av de som kom inn på apoteksiden, gikk videre til informasjonssiden og flere kom også tilbake, forteller Jordbru. Det falske nettapoteket finner du her: www.pharmacyforyou.no
(legemiddelverket.no)
- Som YS-leder minner jeg om at ansatte, tillitsvalgte og medlemmer i YS bør vurdere andre selskaper enn Ryanair når de skal fly, enten dette gjelder fritids- eller tjenestereiser. YS-ledelsen, sentralstyret og de ansatte i YS-sekretariatet er pålagt å ikke fly Ryanair, sier Jorunn Berland.
- YS-forbundet Parat har de siste dagene avdekket og synliggjort svært alvorlige mangler ved lønns- og arbeidsvilkårene i Ryanair. For tre år siden fattet sentralstyret i YS et vedtak som påla både YS-ledelsen, sentralstyret og de ansatte i YSsekretariatet å ikke fly med Ryanair under tjenestereiser. Vedtaket gjelder fortsatt. Vi flyr ikke med Ryanair, sier YS-leder Jorunn Berland.
Farmasiforbundet var blant de første YS-forbundene som fattet lignende vedtak, og mange har kommet etter.
- Den samme oppfordringen går til alle norske forbrukere: Velg et annet selskap enn Ryanair når du skal ut og reise, enten det er i forbindelse med jobb, eller som privatperson, sier Journn Berland.

Farmasiforbundet har igjen vært med på å koordinere det årlige møtet for lærerne ved apotekteknikerutdanningene rundt omkring i landet.
Årets samling foregikk i Halden 4. - 5. mars. Lærerne på denne skolen sto for arrangementet og hadde flere interessante temaer på planen. Praksis, eksamen, dataprogram, fagsammensetning og utdanningsmodell var noe av det som ble flittig diskutert.

24. - 25. aprilSentralstyremøte
25. aprilLegemiddeldagen 2013
23. maiLokalgruppemøte i Førde
13. - 14. juniSentralstyremøte
25. juniNy utgave av Farmasiliv
31. august - 5. september FIP-kongressen
6. – 8. september Årsmøte/tillitsvalgtsamling Region øst
10. septemberNy utgave av Farmasiliv
14. - 15. september Årsmøte/tillitsvalgtsamling Region sør
14. – 15. oktober Kurs for tillitsvalgte trinn III
19.- 20. oktober Årsmøte/tillitsvalgtsamling Region vest
29. oktoberNy utgave av Farmasiliv
30. oktober
- 1. november Farmasidagene
17. desemberNy utgave av Farmasiliv
Oppdatert kalender finner du alltid på www.farmasiforbundet.no
Med forbehold om feil. Finner du feil eller mangler, ta kontakt!
I tida som kommer vil Farmasiforbundet satse enda mer på fag og yrke. Farmasiforbundet skal bidra til å utvikle yrkesrollen, og dessuten være en premissleverandør på det apotekfaglige området. I de neste utgavene av Farmasiliv setter vi derfor fokus på framtidas apotek – hvordan ser norske apotek
Det er spennende, utfordrende og vanskelig å spå om fremtiden, men ett er sikkert - faghandelen apotek vil utvikle seg mer de neste 10 årene enn de siste 10 årene. Samfunnet vårt står overfor store helseutfordringer og i dag er apoteket en ubrukt ressurs i helsevesenet.

Tekst: Margrethe Sunde, administrerende direktør, Boots Norge
Om ti år tror vi det vil være større variasjon i apotektyper. Vi vil ha flere spesialiserte apotek, herunder rene nettapotek, og flere store apotek i sentrale strøk. Kanskje blir de små apotekene mindre og i trafikknutepunkt. Apotekene vil ha et bredere utvalg av varer og tjenester enn i dag, og folk vil møte gode “digitale hjelpere” i tillegg til faglig kompetente og dyktige medarbeidere. Kommunikasjon blir viktigere og det blir store endringer i sortimentet, særlig på tjenestesiden.
«Apotekene
vil ha et bredere utvalg av varer og tjenester enn i dag.»
Dette vil prege utformingen av apotekene, med både terminalplasser av ulike slag og avlukker/informasjonsrom slik at informasjon og tjenester kan utføres med høy diskresjon. Hvordan folk vil få sine produkter og veiledning vil kunne tilpasses kundenes behov på en helt annen måte enn i dag, gjennom samspill med digitale løsninger. Vi tror likevel at det fysiske apoteket og de dyktigste medarbeiderne vil bestå.
I dag er nesten alle medarbeidere i apotek utdannet helsepersonell, først og fremst farmasøyter og apotekteknikere. I fremtiden venter vi å se flere yrkesgrupper, som for eksempel sykepleiere, fysioterapeuter og hudpleiere.
«Det fysiske apoteket og de dyktigste medarbeiderne vil bestå.»
Antall eldre vil øke og det er forventet fortsatt vekst i mange folke- og livsstilssykdommer. Apotekene er klare til å hjelpe til med utfordringene; først og fremst bidra til at flere bruker medisinene sine riktigere, men også som aktiv tilbyder av helsetjenester og veileder på folkehelseopplysningsområdet. Apoteket er en ubrukt ressurs på forebygging av folkesykdommer som hjerte/kar, diabetes, astma og fedme.
I et helsevesen under press er det nødvendig å se med nye øyne på oppgavefordelingen. Dette har vi i Boots kalt helsetrappen. For eksempel kunne enkelte legemidler som i
ut om 10 år? I hvilken retning utvikler apotekbransjen seg? Dette er bare to av spørsmålene vi har stilt forskjellige aktører i bransjen, og først ut til å dele sine betraktinger er administrerende direktør Margrethe Sunde i Boots Norge.

Illustrasjon: Lena Asgeirsdottir
dag er på resept, leveres ut i apotek innenfor bestemte faglige rammer og uten legebesøk. Eksempler er p-piller, legemidler ved øyekatarr og legemidler ved ukompliserte urinveisinfeksjoner hos voksne kvinner. I USA og Storbritannia utfører apotek vaksinering. Dette er en et realistisk scenario også i Norge. Folk vil også oppleve det som helt naturlig å gå på apoteket for oppfølging, for eksempel måling av blodtrykk, blodsukker og kolesterol.
Kanskje utvider apotekene sine tjenester til å reise hjem til folk, for eksempel til kreftpasienter som på grunn av cellegift har vanskelig for å svelge medisinene sine. En farmasøyt kan veilede og gi råd slik at denne pasienten kan få tatt medisinen sin, unngå uheldige interaksjoner, sikre produksjon av tilpassede doser osv. I 2023 har vi også fått på plass en finansieringsordning for multidose til privatpersoner med medisinsk behov. Med slike tjenester kan apoteket ha blitt et nyttig trinn før hjemmesykepleien må inn i bildet.
Vi forventer en utvikling, både i omfang og kvalitet, av diagnostiske tester. Her vil apotekene, der det er relevant, ha en naturlig plass, både i rådgivning, gjennomføring og oppfølging. Allerede i dag tilbyr Boots apotek skanning av føflekker. Dette er en høyteknologisk og viktig kvalitetssikret tjeneste som gjennomføres i samarbeid med hudleger hos ScreenCancer. Tjenesten har avdekket mer enn 60 tilfeller av kreft og flere hundre tilfeller av solskader som bør behandles.
«Apoteket er en ubrukt ressurs på forebygging av folkesykdommer»
Apotek er lavterskel helsetjeneste med god tilgjengelighet, lange åpningstider og kompetent helsepersonell og vil i 2023 være en høyt verdsatt samarbeidspartner med en tydelig plassering i helsevesenet.
Når en kunde faller om i apoteket, er ikke Anita Kopperud ved Boots apotek
Strømmen sen om å reagere. Hun har opplevd alt fra små kuttskader til dødsfall gjennom sine mange år i apotek. Kunnskap, erfaring og kollegialt samarbeid gjør
henne trygg på at hun kan være til avgjørende hjelp i en akutt situasjon.
Tekst og foto: Kristin Rosmo

Anita Kopperud har 30 års erfaring som apotektekniker, og har opplevd mange episoder med kunder som har hatt behov for en hjelpende hånd. Hun har erfart at man aldri kan være helt forberedt. – Man kan aldri vite hvorfor en kunde blør, kaster opp, snubler eller besvimer, og man må rett og slett bare tørre å hjelpe ved å bruke seg selv, sine erfaringer og det man har lært om førstehjelp. Ofte kommer vi veldig langt med å hjelpe folk med å få satt seg, gi dem litt vann og stelle godt med dem, forteller den erfarne apotekteknikeren.
Det kan være alvor
Den opplevelsen som har festet seg for evig og alltid, er et dødsfall i et annet apotek Anita jobbet i for flere år siden.
– Intuisjonen førte meg bort til en eldre mann som på ett eller annet vis hadde en litt unormal atferd. Da jeg kom bort til han var leppene blå, og jeg hørte en surklende lyd, minnes hun. Anita forteller at to kolleger umiddelbart startet livreddende førstehjelp, mens hun selv fikk tak på en lege.
– Dessverre døde mannen på sykehuset etter kort tid. Opplevelsen var en viktig vekker for meg og preger meg den dag i dag, selv om det er mange år siden dette skjedde. Jeg er derfor veldig på vakt når noen faller om i apoteket, forklarer hun.
Kunder i apotek er gjerne litt mer utsatt for akutt sykdom enn befolkningen ellers, og apotekansatte må være forberedt på å oppleve litt av hvert av akutte situasjoner.
– Det beste vi kan gjøre er å holde oss oppdatert på livreddende førstehjelp, vite hvem vi skal kontakte for assistanse og rett og slett gjøre vårt beste som medmenneske, mener Anita.
Boots apotek Strømmen holder til på Strømmen storsenter. Senteret har hjertestarter, og Anita mener det er betryggende at vekterne alltid har med seg hjertestarter når de blir tilkalt pga. akutte situasjoner.
Stole på egen kompetanse
For noen år tilbake arrangerte apoteket et førstehjelpskurs for ansatte. – Det var veldig nyttig, slår Anita fast. Hun har erfaring med mer eller mindre alvorlige hendelser i apotek, og forteller at hun føler seg trygg på at hun kan hjelpe mennesker i en akutt situasjon. Hun mener man ikke trenger å vite alt, men at prinsippene for livreddende førstehjelp bør
sitte i ryggmargen hos alle som jobber på apotek. – Å legge folk i stabilt sideleie for å åpne luftveiene f.eks. – det er vi gode på her hos oss i alle fall, smiler apotekteknikeren med det varme hjertet.
Anita er også opptatt av det kollegiale samholdet når noe skjer. – Samholdet er viktig både mens det står på, og ikke minst er det viktig å få pratet seg gjennom hendelsen i ettertid, påpeker hun.
– Gjør man sitt beste ved å kjenne til prinsipper for livreddende førstehjelp og vise handlekraft når noe skjer, skal man ikke gå rundt å ha skyldfølelse for ikke å ha hjulpet godt nok, er Anita Kopperuds oppfordring til apotekkolleger.
Apotekkjedene svarer:
Farmasiliv har spurt alle apotekkjedene og sykehusapotekforetakene om hvordan de generelt lærer opp/forbereder ansatte til å møte akutte situasjoner som oppstår hos kunder. Ikke alle har valgt å svare på dette. Men både Boots og NMD forteller at de har prosedyrer rundt akutt sykdom/skade, og flere primær- og sykehusapotek har gjennomført førstehjelpskurs lokalt.
Tekst: Kristin Rosmo
Boots apotek har en egen prosedyre for hvordan medarbeidere i apotekene skal opptre ved alvorlig personskade og akutt sykdom i apoteket, enten det gjelder kunder eller ansatte.
– Prosedyren er lik for alle våre apotek, men det er den lokale apotekeren/lederen som har ansvaret for at ansatte vet hva de skal gjøre og for at nødvendig utstyr er på plass, sier HRdirektør i Boots, Harald Johnsrud. Opplæring skjer lokalt.
– Boots sender også ut et årlig skriv til apotekene med faste oppgaver og ulike temaer innen HMS, og dette inneholder også informasjon om førstehjelp, forteller Johnsrud. NMD har så langt ikke kjørt egne førstehjelpskurs på kjedenivå rettet mot medarbeidere i apotek. Men noen av apotekene har gjennomført kurs i førstehjelp på eget initiativ.
– Vi er straks klare med en ny beredskapsprosedyre hvor de viktigste livreddende tiltakene er beskrevet, sier Terje Kvaal, direktør NMD Apotekhandel.
– De tilfellene vi kjenner til med akutte førstehjelpstilfeller i apoteket er håndtert profesjonelt av våre medarbeidere. I disse dager er dessuten instruksjonsplakater med hva man gjør i ulike førstehjelpstilfeller på vei ut til alle våre apotek, opplyser han. Sykehusapotekene i region Helse Sør-Øst er ikke pålagt å gjennomføre opplæring innen førstehjelp.
– Selv om våre sykehusapotek er lokalisert på sykehus, har likevel mange valgt å gjennomføre denne type opplæring, sier områdedirektør Bente Hayes.
Førstehjelp, den første hjelpen du gir til en person som enten er blitt alvorlig syk eller skadd, kan være avgjørende både for overlevelse og rekonvalesens. Dersom du tar ansvar og utfører noen enkle grep for å hjelpe den som er syk eller skadet, kan det være du som utgjør forskjellen.
Tekst: Kristin Rosmo
– All førstehjelp handler om å handle raskt, riktig, og i en prioritert rekkefølge, forteller spesialrådgiver/førstehjelpsansvarlig i Røde Kors, Peter Meyer. Han anbefaler alle arbeidsgivere å tilby førstehjelpskurs for sine ansatte, men forteller Farmasiliv mer enn gjerne hvilke enkle tiltak man kan utføre for å avhjelpe i en kritisk situasjon.
– Frie luftveier, pust og sirkulasjon er de tre første og viktigste livreddende tiltakene, poengterer han. Disse prinsippene gjelder uansett hva som er årsaken til at en person trenger førstehjelp.
Det første man skal forsikre seg om er at pasienten har frie luftveier. – Dette enkle tiltaket alene kan redde et menneskeliv, forklarer Meyer. Når frie luftveier er etablert skal man vurdere om pasienten puster normalt før man sjekker om sirkulasjonen er truet.

Spesialrådgiver/førstehjelpsansvarlig i Røde Kors, Peter Meyer, anbefaler alle arbeidsgivere å tilby førstehjelpskurs for sine ansatte. Foto: Røde Kors
«Å gi frie luftveier kan alene redde et menneskeliv»
Peter Meyer, Røde Kors
Førstehjelpsappen til Røde Kors kan lastes ned fra: www.rodekors.no/forsthjelpsapp/ Den inneholder mange gode tips, men erstatter ikke et kurs i førstehjelp.
Kilde: Røde Kors
– I mange miljøer snakker man om ABC, som er en betegnelse for «Airway, Breathing, Circulation», sier Meyer og forklarer at dette er det samme som frie luftveier, pust og sirkulasjon. Han forteller at såkalt agonal pusting (gisping/ snorkelyder) ofte har blitt tolket som at pasienten puster. Dette er imidlertid ikke normal pust.
– Dersom man ikke kan høre vanlig pustelyd eller se om brystkassen hever/ senker seg skal man begynne med hjerte-/ lungeredning, presiserer spesialrådgiveren i Røde Kors.




Hjerte-/lungeredning må læres på kurs, men her er en kort beskrivelse av fremgangsmåten:
• Legg personen på ryggen
• Fjern unødvendig bekledning som hindrer deg i å plassere hendene/trykke riktig
• Sett deg på knærne ved siden av pasientens bryst
• Plasser en hånd med håndroten/håndbaken midt på brystet og den andre hånden oppå
• Trykk 30 ganger
• Gi pasienten frie luftveier og blås 2 ganger
• Trykk så 30 ganger igjen og blås 2 ganger og fortsetter med dette til ambulansepersonellet ankommer
I en situasjon med en tilsynelatende livløs person må det varsles 1-1-3 UMIDDELBART!
Kilde: Røde Kors
Frie luftveier: bøy hodet bakover og løft frem haken; legg en hånd på pannen og fingertuppene på den andre under fremre hakeparti på personen og vipp hodet lett bakover. Normal pust: Legg øret mot personens munn og hør etter normale pustelyder. Se samtidig nedover brystet for å se om brystkassen hever og senker seg.
Sirkulasjon: Stans eventuelle blødninger og løsne opp på bekledning etc. som kan hindre sirkulasjonen.
Mens du sjekker personen og utfører disse tiltakene, så få en kollega til å ringe 1-1-3 for assistanse.
Kilde: Røde Kors























Vaxol ørespray er en unik og etterlengtet nyhet. Endelig har det blitt enkelt å holde ørene rene på en sikker og naturlig måte. Vaxol inneholder farmasøytisk renset olivenolje med antibakterielle og fuktbevarende egenskaper.
5 gode grunner til å anbefale Vaxol:
Mange mener mye i Farmasiforbundet – både i sekretariatet og blant sentrale og lokale tillitsvalgte. Det er bra!
Meninger fungerer imidlertid best når de deles med andre, og på Farmasiforbundets nettsider farmasiforbundet.no har vi derfor samlet en rekke meningsfulle tekster under vignetten «Meninger». Hva mener du? Du er hjertelig velkommen til å bidra, sett deg ned og skriv, og send din tekst til vetle.daler@farmasiforbundet.no. Her får du utdrag fra to av disse tekstene, skrevet av nestleder Bodil Røkke Havig og fagsjef Berit Regland.
Bodil Røkke Havig: En vanvittig viktig samfunnsoppgave

Når jeg valgte å bli apotektekniker var det et helt bevisst valg. Ønsket om å gjøre en samfunnsnyttig oppgave innen helsesektoren uten direkte å jobbe med pleie gjorde at apotektekniker var midt i blinken for min del. I 13 år har jeg nå jobbet som apotektekniker, og jeg blir bare mer og mer overbevist om at jeg og yrkesgruppen gjør en vanvittig viktig samfunnsoppgave.



I Farmasiforbundet er det bred enighet om at vi må ha et sterkere fokus på det apotekfaglige og da spesielt fokus på apotekteknikeren som yrkesutøver.
Hvorfor gjør vi dette i en tid der våre medlemmer gir tydelige signaler om at det er tariff og forhandlinger vi må ha fokus på?
For å ta det siste først: Alt henger sammen med alt. Å sikre trygge, forutsigbare og gode arbeidsforhold vil alltid være i sterkt fokus i Farmasiforbundet. Vi vil aldri miste fokus på dette. Vi setter derfor inn flere støt som styrker kompetansen på dette området.
Når vi møter arbeidsgiver til forhandlinger i mai-juni bygger vi argumentasjonsreken vår på det som skjer ellers i året. Det nytter ikke å komme til forhandlingsbordet med argumenter som «vi vil ha». Arbeidsgiver ønsker å vite hvilken merverdi det ligger i å satse på apotektekniker som yrkesgruppe.
Denne merverdien må vi bli flinkere til å formidle. Når vi nå bygger en tydeligere fagpolitikk er det fordi vi ønsker å bevisstgjøre yrkesgruppen selv, arbeidsgiver og samfunnet forøvrig om at vi er en yrkesgruppe som vil og skal være en aktør som bidrar til at apoteket også i fremtiden består som en solid faghandel.
Berit Regland:
En beskyttet tittel?

Siden 2001 har apotekvirksomhet vært omfattet av «lov om helsepersonell» i form av at alle utdanningsgrupper i apotek er autorisert som helsepersonell. Farmasiforbundet var en aktiv pådriver for å nå det målet.



Hovedgrunnen er at kunder og pasienter på apoteket skal oppleve trygghet og forutsigbarhet. Eller som det står i formålsparagrafen til loven: «Lovens formål er å bidra til sikkerhet for pasienter og kvalitet i helsetjenesten samt sikre befolkningens tillit til helsepersonell og helsetjenesten». Det er fagpersonalet på apotekene som skal bygge denne tilliten på kvalitet og kunnskap.
Helsepersonelloven beskriver hvilke yrkestitler som er godkjent og betyr i praksis at titlene er beskyttet. Hvordan virker så dette i apotekene? I årenes løp har rekrutteringen blitt preget av mer mangfold. Vi har fått andre helsepersonellgrupper som kollegaer, ufaglærte med ymse bakgrunn, for eksempel studenter og elever. Det er rekruttert ansatte med utdanning fra andre land.
Les resten på farmasiforbundet.no




– nå vil










Grønt Punkt sikrer at all emballasje som kildesorteres og samles inn blir gjenvunnet. Hvis dere bruker eller produserer produkter med emballasje uten å være medlem, er det noen andre som må ta regningen. Bli medlem slik at vi får en rettferdig fordeling av gjenvinningskostnadene. Kontakt oss på www.grøntpunkt.no eller ring 22 12 15 00


Grønt Punkt – for bedrifter som tar samfunnsansvar





Apotektekniker Ann Kristin Skogli (34) har ikke tenkt så mye på pensjon, i likhet med så mange andre. Hvordan ligger hun egentlig an?
Tekst: Torunn Dillan Pedersen Foto: Vetle Daler
- Jeg har tenkt at det er så lenge til jeg blir pensjonist, og at pensjon er noe jeg kan ta meg av siden. Jeg vet jo at det ikke er så lurt å tenke sånn, sier Skogli. Hun har Sykehusapoteket Oslo på Ullevål sykehus i Oslo, som arbeidsplass, og trives godt. Nå merker hun også en gryende interesse for pensjon.
- Da jeg startet i jobben var ikke pensjon noe tema. Men nå har jeg begynt å høre etter når mine eldre kolleger snakker
om pensjon. Det er nok på tide å bli litt mer voksen og yte livet fremover flere tanker, forteller hun.
Har ikke undersøkt
Skogli har ikke undersøkt med NAV hvor mye alderspensjon hun har opptjent. Hun har heller ikke trodd at hun var kommet langt i opptjeningen av tjenestepensjon, men her








Telfast – reseptfritt antihistamin som gjør deg lite trett1








Nasacort – potent kortisonspray mot allergisk rhinitt2 i2




Reseptfri allergimedisin
Telfast® 120 mg tabletter (feksofenadinhydroklorid) (10 og 30 stk.) – ved allergiske nese- og øyeplager hos voksne og barn over 12 år. Nasacort® 55 mikrogram/dose, nesespray, suspensjon (triamcinolonacetonid), 30 doser – nesespray ved sesongbetonte allergiske reaksjoner i nesen hos voksne (18 år eller eldre).
Referanser: 1) 2) 3) 4)
www.allergihjelpen.no
venter en god nyhet. Med drøyt 12 års langt medlemskap i Pensjonsordningen for apotekansatte (POA), har hun allerede gått en tredjedel av veien mot full opptjening, som er 30 år. Men slutter hun og begynner i privat sektor, kan opptjeningskravene økes til 40 år. Derfor må hun vite hvilke økonomiske konsekvenser det kan få å skifte arbeidsgiver, for eksempel bør hun sjekke om hun fortsatt har rett til å ta ut Avtalefestet pensjon (AFP). For mange som har en fysisk krevende jobb, er det et viktig alternativ.
- De siste årene har jeg jobbet i produksjon, slik at jeg ikke lenger står i skranken, som kan være tungt for ryggen. Jeg trives veldig godt i jobben min. Jeg har tenkt å jobbe så lenge jeg kan og har noe å gi, sier Skogli.
Mer enn bare alderspensjon
Enn så lenge er det ikke mulig å beregne Skoglis totale alderspensjon. Det er fordi regelverket for offentlig tjenestepensjon, som POA er nært knyttet til, ikke er klart
Vet du noe om din pensjonsopptjening? Her er noen tips til hvordan du kan få mer oversikt.
• Det første du bør gjøre, er å sjekke hvordan du ligger an når det gjelder pensjon. Det kan du blant annet gjøre på www.nav.no/dinpensjon.
• Medlemmer i POA kan sjekke opptjeningen av tjenestepensjon på www.spk.no, som er nettsidene til Statens pensjonskasse.
• På www.norskpensjon.no kan du få oversikt dersom du har hatt tjenestepensjon gjennom flere leverandører enn POA.
• Sett deg inn i hvilke andre rettigheter enn alderspensjon du og evt. din partner har gjennom arbeidsgiver. Hvis en av dere blir ufør, får det mye å si for den totale økonomien.
• Hvis du vurderer å skifte jobb, slik at du får en annen type tjenestepensjon enn du har hatt gjennom POA, må du sette deg godt inn i hva du har og hva du blir tilbudt.
• Lurer du på noe om tjenestepensjonen din gjennom POA, kan du lese mer om ordningen på www.spk.no. Du kan også kontakte kundesenteret i Statens pensjonskasse.
ennå for de som er født etter i 1954 eller senere. Men det som er klart, er at hver enkelt må regne med å jobbe lenger enn tidligere årskull for å oppnå samme pensjon som før pensjonsreformen.
- Det er ikke det at pensjon er så vanskelig. Det er bare det at det er så lenge til at jeg blir pensjonist, men der må jeg kanskje tenke nytt nå og ta bedre ansvar for meg og mine, sier Skogli, som lenge har trodd at tjenestepensjon bare handler om alderspensjon. Men medlemskapet i POA inkluderer også uførepensjon, ektefellepensjon og barnepensjon. Det betyr mye hvis hun får egne barn en dag og har behov for å vite at familien er økonomisk sikret. Eller hvis hun skulle bli ufør. Det er nemlig sånn at hva tjenestepensjonsordningen din er verdt, merker du den dagen du virkelig trenger den.









Halsbrann og sure oppstøt kan skyldes alt fra stress og sterk mat, til overvekt og problemer med en slapp lukkemuskel mellom spiserør og magesekk.
Gaviscon® virker mekanisk gjennom å legge seg som et lokk oppå mageinnholdet, og lindrer uten å påvirke kroppens naturlige funksjoner. Effekten varer i flere timer eller til du spiser neste gang.



Gaviscon (alginat) er et reseptfritt legemiddel som brukes ved gastroøsofageal reflukssykdom. Indikasjoner: Refluksøsofagitt. Symptomatisk behandling ved spiserørsbrokk, sure oppstøt eller halsbrann. Dosering: Tyggetabletter: 1–3 tyggetabletter tygges grundig ½ time etter måltid, ved behov samt rett før sengetid. Mikstur (oral suspensjon): 10–20 ml ½ time etter måltid, ved behov samt rett før sengetid. Sortiment: Tyggetabletter: 20 stk. og 120 stk. blisterpakning. Mikstur (oral suspensjon): 100 ml og 500 ml plastflaske. Les alltid nøyaktigt på pakning og pakningsvedlegg. Siste revisjon av preparatomtale: 2005-12-15 (tyggetabletter) 2008-12-30 (mikstur). Nordic Drugs, Tlf 23 22 11 44, E-post: info@nordicdrugs.no
Kvinner har oftere smerter en menn, de har mer kroniske smerter og forskjellen bare øker med alder.
Tekst: Ellenor Mathisen
Norge ligger på smertetoppen i Europa. Kroniske smerter og psykiske lidelser er det viktigste årsakene til at både menn og kvinner faller ut av arbeidet. Men det er betydelig flere kvinner enn menn som sier at de har kroniske smerter, og kvinner er også oftere sykemeldt eller uføretrygdet pga kroniske smerter. Forbruket av smertestillende medikamenter har økt kraftig fra 1999 til 2008, og mange av disse er vanedannende. Dette kom fram på Smerteforum, en konferanse med fokus på kvinnehelse og smerteproblematikk som ble avholdt i Oslo i forrige måned.
Optimistisk holdning
Anestesilege ved Bærum sykehus, Alf Kristoffer Ødegaard, påpekte i sitt innlegg at det likevel er viktig å ha en optimistisk holdning for å forebygge depresjoner og hindre at pasientene blir avhengig av medikamenter. Den gode nyheten er at de fleste blir bedre over tid.

Ødegaard mente at behovet for behandling er individuelt. Det vil si at noen kan ha behov for smertelindrende medikamenter, men at dette er noe man bør være forsiktig med.
– Vi vet at smerte skaper smerte. Det er derfor viktig å hindre eller lindre akutte smerter. Jo flere smertefulle opplevelser en kvinne har hatt, desto lavere smerteterskel vil hun kunne få. Smertefulle tilstander forsterker hverandre, og jo nærmere de ligger anatomisk, desto mer smerte kan det forårsake. Opplevelsen av smerte blir lagret i sentralnervesystemet, og kan føre til en varig endring i nervecellenes funksjon.
Ødegaard forklarte dette med at intens, vedvarende smerter kan etterlate seg såkalte hukommelsesspor.
– Kvinnen kan derfor oppleve samme type smerte som tidligere ved minimal stimulering av det somatosensoriske systemet. Hun opplever samme type smerte som tidligere, til tross for at vevet ikke er sykt.
Ødegaard mente at grundig informasjon om hva legen finner ut om tilstanden, er viktig. Men like viktig er det å fortelle pasienten om hva man ikke har funnet ved undersøkelsen.
– Vi må fortelle pasienten at vi skjønner at hun har det vondt. Hvis ikke, brytes tilliten til pasienten.
Han fortalte også at bruk av en kognitiv behandlingsmodell også hadde gitt gode resultater, og at det derfor er viktig å opprette et samarbeid med psykolog eller psykiater.
Psykososiale forhold
Han påpekte at det likevel er svært viktig å behandle akutte smerter slik at pasientens tilstand ikke forverrer seg.
– Kronisk smerte er sjelden resultat av én enkelt faktor, og det som utløste smerten har nødvendigvis ikke en nær sammenheng med det som vedlikeholder den.
Undersøkelser viser at mange kvinner har en livshistorie
Anestesilege Alf Kristoffer Ødegaard påpekte i sitt innlegg at det er viktig å ha en optimistisk holdning for å forebygge depresjoner og hindre at pasientene blir avhengig av medikamenter.
som bærer preg av f eks betydelige problemer i parforhold. Store psykososiale problemer er også ganske vanlig, og forskning viser at psykiatrisk lidelse også kan være tilstede.
Kjønnsforskjeller
Tromsøundersøkelsen (Tromsø Pain Study) har helt siden 1974 bidratt til vesentlig forskning ved Det helsevitenskapelige fakultet, Universitetet i Tromsø (UiT). Den siste ble utført i tidsrommet 2007-2009, og totalt har over 38 000 personer deltatt. Også her viser undersøkelsene at kvinner har mer smerte enn menn.
Christopher Sivert Nilsen er psykolog ved Folkehelseinstituttet. Han samarbeider med UiT og Oslo Universitetssykehus (OUS) i det som er verdens største studie av smertefølsomhet. Her forsøker forskerne å finne årsaken til kroniske smerter. Nilsen fortalte at smerter er et stort helseproblem i Norge.
Kroniske smerter hos nordmenn ligger på cirka 30 prosent. Det er betydelig høyere enn i Sverige og Danmark, hvor den ligger på cirka 16-19 prosent.
Uføretrygdet
Nilsen fortalte at forskerne ikke vet hvorfor det er så mange nordmenn som har kroniske smerter.
– Psykiske lidelser er en stor utfordring for helsemyndighetene. Vi ser at cirka en fjerdedel av den norske befolkning kommer til å få en angstlidelse i løpet av sitt liv. Men han påpekte at forekomsten av psykiske lidelser i Norge ikke har økt de siste årene; det er oppmerksomheten rundt sykdommene som har økt. Forskning viser at psykiske lidelser ofte starter i barne- og ungdomsårene eller tidlig i voksenlivet. Enkelte sliter derfor med tilbakevennende dårlige perioder nesten hele livet.

I debatten kom det fram at fagfolk ønsker flere smerteklinikker rund om i landet. Fra venstre: Stortingsrepresentant Kari Kjønaas (FrP), statssekretær Kjell Erik Øie (Ap), president i Legeforeningen, Hege Gjessing, administrerende direktør i Legmiddelindustrien, Karita Bekkemellem og anestestilege (OUS) Audun Stubhaug.
Fagfolk etterlyser et bedre tilbud til pasienter med kroniske smerter.
I debatten etterpå deltok bl a statssekretær Kjell Erik Øie fra Helse- og omsorgsdepartementet (HOD). Øye svarte på kritikken fra flere fagfolk, som lenge har etterlyst et bedre tverrfaglig tilbud til pasienter med kroniske smerter. Statssekretæren sa at departementet nå vil se nærmere på hvorfor helseforetakene ikke har fulgt opp departementets oppdrag om å etablere flere smerteklinikker rundt om i landet.
Professor Audun Stubhaug ved Avdeling for smertebehandling, OUS, påpekte at dette kan skyldes
mangel både på kompetanse og fagfolk. Han etterlyste derfor ressurser og konkrete planer for hvordan man kan bygge opp egne fagmiljøer på smerteområdet.
Må få kompetanse
Anestesilege Nils Moe, som er privatpraktiserende spesialist, påpekte at det i dag bare er sykehusspesialister som kan skrive ut svært sterke smertelignende legemidler i morfingruppen.
– Hvis allmennleger fikk nødvendig kompetanse slik at også de kan starte smertebehandling – men med refusjonsansvar – kan tilbudet bli mye bedre. I dag er det kun få allmennleger som har kompetanse på dette området, og jeg må bruke mye tid på søknader om refusjon, fortalte han.
Også administrerende direktør i Legemiddelindustrien, Karita Bekkemellem, mente at smerteområdet nå må få mer oppmerksomhet fra politikerne. Mens president i Legeforeningen, Hege Gjessing, fortalte at de nå vurderer om det skal opprettes et eget kompetansesenter for smertemedisin.

Kroniske smerter defineres oftest som smerte med varighet på seks måneder eller mer. Det er vanlig å skille mellom tre hovedtyper:
• Nosiseptiv smerte skyldes vevskade, f eks revmatiske leddsykdommer med leddskade.
• Nevropatisk smerte skyldes dysfunksjon i nervesystemet (isjias).
• Idiopatisk smerte eller sammensatt smerte, av ukjent årsak – f eks uspesifikke rygg- og nakkesmerter.
De hyppigste kroniske smertetilstandene oppstår i muskler og skjelett. Dette er oftest uspesifikke rygg- og nakkesmerter og andre av ukjent eller sammensatt årsak. Men det kan også være smerter som skyldes trykk på nerverot (isjias) og ulike revmatiske lidelser.
Andre kroniske smertetilstander inkluderer hodepine, ulike mage- og underlivssmerter, smerter etter skader og kirurgi, smerter i forbindelse med hjertekarsykdommer og nevrologiske lidelser.
Kroniske smerter øker risikoen for redusert psykisk helse og faren for avhengighet av vanedannende medisiner. Kroniske smertepasienter har to til fire ganger høyere forekomst av angst og depresjon, og dobbelt så stor forekomst av selvmord – sammenlignet med den øvrige befolkningen. Søvnproblemer er også vanligere.
Genetiske faktorer har betydning for utvikling av kroniske smertetilstander og for smertefølsomhet. Tvillingstudier viser at om lag halvparten av risikoen for å utvikle kroniske smerter skyldes genetiske faktorer (30-70 prosent).
Den vanligste behandlingsmetoden for kroniske smerter er smertestillende midler. Både opioider og NSAID benyttes. I 2011 fikk cirka 200 av 1000 menn og 250 av 1000 kvinner under 80 år utlevert et smertestillende middel på blå resept; totalt cirka 1 million personer. I tillegg ble det solgt reseptfrie midler tilsvarende 70 smertestillende tabletter per person i 2008.
(Kilde: Folkehelseinstituttet)
Spermiene trives best om vinteren. Da er de mange, de svømmer fortere og er friskest.
Det finnes en sesong for det meste her i verden, og nå har forskere sett at også spermier har en høy- og lavsesong. Høysesongen viser seg å være på vinteren; da er antall spermier høyt, svømmehastigheten er god og de fant færre uregelmessigheter. Tidlig vår kan også passere, men så går det raskt nedover med kvaliteten. Det viser en israelsk studie publisert i tidsskriftet American Journal of Obstetrics & Gynecology.
Sesongavhengig
Forskerne analyserte sædprøver fra 6455 fra menn som hadde oppsøkt en infertilitetsklinikk i en periode på vel tre år. Av alle disse prøvene viste det seg at 4960 hadde normale funn når det gjaldt antall spermier, mens 1495 avvek fra normalen. Disse hadde et lavt antall spermier.
Verdens Helseorganisasjon definerer alt over 15 millioner spermier per milliliter som normalt.
Kroppen bruker cirka 70 dager på å produsere en spermcelle. Forskerne fant da ut at menn med normal spermieproduksjon, hadde de friskeste spermiene om vinteren.
Raske svømmere
Hvis menn produserer cirka 70 millioner spermier per milliliter om vinteren, vil rundt fem prosent av disse være såkalte ’raske’ svømmere.
Sammenlignet med antall spermier mennene produserte om våren, var gjennomsnittet på 68 millioner spermier per milliliter. Her var bare tre prosent raske svømmere – noe som igjen påvirker kvinnens muligheter for å bli gravid.

Forskerne mener derfor at denne nye kunnskapen blir viktig for par som sliter med å få barn.
De så også at menn som hadde et lavt antall spermier, ikke ble påvirket av årstidene. Men de hadde derimot en svak tendens til å ha bedre kvalitet på spermiene om høsten. I tillegg fant forskerne at mennene hadde den største prosentandelen friske spermier (cirka sju prosent) om våren.
Årstider
Antall spermier endrer seg også med årstidene hos dyr. Forskerne tror det kan skyldes ulike årsaker som
temperatur, antall timer med dagslys og endring i hormonene.
Undersøkelser viser at antall spermier hos menn verden over, synker. Forskerne vet ikke hvorfor dette skjer, og teoriene er mange. Alt fra et stillesittende liv til ulike kjemikalier som kan ha en negativ påvirkning på spermiene. Men forskerne er enig om at spermiene påvirkes av årstidene og at ulike ting i miljøet ser ut for å endre fertiliteten hos menn.
Livsstil
eller årstid kan ha betydning for kvaliteten på spermiene.
Tekst: Ellenor Mathisen
Trine B. Haugen er professor i biomedisin og prodekan for forskning og utvikling ved Høgskolen i Oslo og Akershus.
Hun sier i en kommentar at studien er interessant, spesielt fordi det var mange menn som deltok.
– Ulempen er at de ikke ble plukket ut av den generelle befolkningen, men at dette var deltakere som hadde oppsøkt en infertilitetsklinikk.
Haugen påpeker at når menn har få spermier, er det også vanskelig å oppdage variasjon. I tillegg kan noen i denne gruppen menn ha sykdommer eller være utsatt for en påvirkning som kan ’overstyre’ eller dominere en mulig sesongvariasjon.
Livsstil
Hun er usikker på om informasjonen om at vinterspermier ser ut for å være av bedre kvalitet, kan være viktig for par som sliter med å få barn.
– Denne studien er gjort på gruppenivå, men det kan selvsagt være slik at noen menn ’balanserer’ på et nivå der en liten oppgang eller nedgang i sædkvaliteten kan ha en betydning.
kunnskap om f eks hormoner eller andre faktorer – som igjen kan brukes i behandling av infertilitet.
Ingen sesongvariasjoner
I en studie som Haugen ledet for cirka 10 år siden, deltok 200 tilfeldige rekrutterte norske menn. Det spesielle med denne studien var at forskerne ønsket å undersøke sesongvariasjon på sædkvaliteten hos menn både nord for Polarsirkelen (Tromsø), med sine ekstreme lysforandringer, og menn som bodde i Oslo. Men de fant ingen slike sesongvariasjoner og ingen geografiske forskjeller.

Trine B. Haugen er prodekan ved HiOA, og sier hun er usikker om vinterspermier er av bedre kvalitet. Andre årsaker kan også spille inn.
Haugen påpeker at livsstilsfaktorer eller årstid kan være avgjørende for at dette tipper i riktig retning. Men på lengre sikt kan det få betydning fordi forskerne får ny
Haugen mener at det likevel ikke betyr at slike variasjoner ikke finnes. Med 200 menn, som i den norske studien, ville kun en forskjell på mer enn 10 millioner spermier per milliliter kunne oppdages.
– Det vi derimot fant, var en liten forskjell i et hormon som er positivt forbundet med spermieproduksjon, inhibin B. Vi så at nivåene av inhibin B var litt høyere om vinteren enn om sommeren – men kun i Tromsø. Det kan være at hormonelle endringer ikke var store nok til å påvirke spermieproduksjonen med det antall menn vi undersøkt, forteller hun.
Gravide med hormonforstyrrende stoffer i blodet, fikk sønner med lavere sædkvalitet.
Tekst: Ellenor Mathisen
Forskere tror at økende eksponering for hormonforstyrrende stoffer i miljøet kan være en av årsakene til lav sædkvalitet. Det viser en ny dansk studie publisert i tidsskriftet Environmental Health Perspective.
Færre sædceller
Resultatene viser at sønnene til mødrene med de høyeste konsentrasjonene av miljøgiften perflyoroktansyre (PFOA) i blodet under svangerskapet, hadde lavere sædkonsentrasjon og totalt færre sædceller –sammenlignet med sønnene til mødre med de laveste konsentrasjonene av PFOA. Stoffet finnes i flere typer tekstiler som bl a GoreTex og sko.
Frosset ned
Forsker Line Småstuen Haug ved Folkehelseinstituttet i
Norge deltok også i denne danske studien. Hun forteller at cirka 1000 gravide kvinner i Århus ble rekruttert til en studie hvor bl a blodprøver av kvinnene ble frosset ned i uke 30 av svangerskapet.
20 år senere ble sønnene fra disse svangerskapene kontaktet og spurt om de ønsket å delta i en oppfølgingsstudie.
Analyser
Forskerne fikk positive svar fra cirka 170 av sønnene som da var mellom 19 og 21 år. De avga så en blodprøve og en sædprøve.
Mengden av perfluorerte alkylstoffer (PFAS) fra mødrenes blodprøver under graviditeten ble analysert og sammenholdt med sønnens sædkonsentrasjon, totalt antall sædceller og kjønnshormonnivå.
Unngå eksponering
Haug forteller at nivåene av PFOA og andre tungt nedbrytbare perfluorerte alkylstoffer på slutten av 1980-tallet i Norge var på samme nivå som i Danmark. – Siden 2000 har disse sunket betraktelig, men det gjelder ikke alle miljøgifter. Det er derfor viktig å ikke bli eksponert for tungt nedbrytbare stoffer for å unngå negative helseeffekter, påpeker hun.
Q-10 og selen kan halvere risikoen for å dø av hjertesykdom.
Tekst: Ellenor Mathisen
En ny svensk studie viser at deltakerne som fikk tilskudd av antioksidantene Q-10 og selen, reduserte risikoen for å dø av hjertesykdom med 54 prosent. Studien ble gjort ved Linköping universitet, og ble ledet av overlege i kardiologi, Urban Alehagen. 433 personer over 70 år deltok, og etter en ultralydundersøkelse av hjertefunksjonen, ble disse delt i to grupper.



– Flere av deltakerne døde av ulike årsaker mens studien pågikk. Men blant gruppen som fikk tilskudd av Q-10 og selen, døde bare seks prosent – mot 12 prosent i kontrollgruppen, forteller han.
Den ene gruppen fikk fire kapsler med Q-10 og selen hver dag, i tillegg til vanlige medisiner. Den andre gruppen fungerte som kontrollgruppe, og fikk bare placebo. Studien var såkalt dobbeltblind; det vil si at verken deltakerne eller forskerne visste hvem som hadde fått hva før etter at studien ble avsluttet etter fire år.
Studien er publisert i det anerkjente tidsskriftet International Journal of Cardiology. Urban Alvehagen forteller at alle i forskergruppen ble meget overrasket over resultatet.
Blant de som fortsatt var i live mens studien pågikk, kunne forskerne se en bedre hjertefunksjon og et lavere nivå av hjertestressmarkører i gruppen som hadde fått aktive substanser. – Vi er fortsatt forsiktig når det gjelder tolkningen av resultatene. Til tross for at vi hadde 443 deltakere og fulgte disse over fire år, trenger vi å gjøre flere studier, påpeker Alehagen.
Kronisk
En italiensk studie publisert i tidsskriftet European Heart Journal i 2007, viste at Q-10 forbedret hjertekapasiteten hos pasienter med kronisk hjertesvikt. 23 pasienter med en gjennomsnittsalder på 59 år og moderat til alvorlig kronisk hjertesvikt, fikk tilskudd av Q-10 eller placebo. Noen av deltakerne trente også fem ganger per uke. Av disse 23, fulførte 21 deltakere
opplegget. Resultatet viste at de som fikk Q-10 hadde tre prosent signifikant økning i HDL-kolesterolet og en forbedret treningskapasitet.
Forskerne så også en økning i hjertefunksjonen hos deltakerne som fikk Q-10. Deltakere som fikk Q-10 og trente i tillegg, hadde en forbedring på alle parametre.
Forskerne bak denne studien konkluderte med at Q-10 kan ha effekt hos pasienter med kronisk hjertesvikt. De fant heller ingen bivirkninger ved bruk av tilskuddet.
– Mangelfull
Professor Lars Gullestad ved Institutt for klinisk medisin, Kardiologisk avdeling, UiO, mener den svenske studien har flere mangler.
– Studien er for liten til at man får skikkelige svar på om tilskudd av Q-10 og selen kan redusere hjertesvikt. Det fremgår heller ikke om hvorvidt de som deltok allerede hadde mangel på Q-10 og selen. I tillegg forsvant mellom 40 og 50 prosent av deltakerne mens studien pågikk – noe som er svært høyt og gjør studien både mangelfull og svak. I beste fall kan den danne et utgangspunkt for en ny og større studie.
En ny studie publisert i tidsskriftet Diabetes Care viser at deltakere med et kosthold som inneholdt mye selen, hadde 24 prosent lavere risiko for å utvikle diabetes type 2 sammenlignet med de som hadde et kosthold med lite selen.
Sporstoff
7000 helsearbeidere ble fulgt over flere tiår, men forskerne bak studien vil likevel ikke anbefale folk å ta tilskudd av selen. Selen er et viktig sporstoff som er en nødvendig komponent i kroppens viktigste antioksidant, glutation peroxidase. Mangel på selen er satt i sammenheng med flere store sykdomsgrupper, som f eks diabetes. – Det finnes mange ulike typer selen, og disse kan ha ulik

flere sykdomsgrupper.
effekt. Selentilskudd man kjøper på boks, inneholder bare én type selen, påpeker dr Dariush Mozaffarian, som er seniorforsker ved Harvard School of Public Health.
Bivirkninger
Forskerne anbefaler heller at man spiser mer egg, helkorn, fisk og skalldyr som inneholder mye selen. Men da er det viktig å påpeke at voksne ikke bør innta mer enn 300-350 mikrogram per dag for å unngå bivirkninger som bl a depresjon, håravfall og anemi.

Medisinske nyheter kan oppfattes som forvirrende og ikke minst – selvmotsigende.
Tekst: Ellenor Mathisen
Alt man endelig hadde lært var både godt og sunt for kropp og sjel, viser seg etter en stund å være det stikk motsatte. Undersøkelser og behandlingsmetoder som har vært ansett som såkalt ’gullstandard’, gjelder plutselig ikke lenger. Mens man tidligere hevdet at en såkalt ’medisinsk sannhet’ hadde en levetid på cirka fem år, har dette nå endret seg til ’ferskvare.’ Spiselig i dag, men helt uspiselig i morgen, for å sette det hele litt på spissen.
Mammografi
Lenge var f eks mammografi sett på som et meget godt tilbud til kvinner fordi man kunne oppdage eventuelle kreftsvulster på et tidlig stadium. Så kommer det nye studier som viser at mammografi også kan oppdage svulster som er helt ufarlige, og som går tilbake av seg selv. Da har allerede mange kvinner fått behandling for noe som ikke skulle behandles, med alt det innebærer av bekymring og smerte.
Igjen sitter forvirrede leger og pasienter som må ta avgjørelser om ulike behandlingsmetoder som kan vise seg å gjøre mer skade enn nytte.
Råd for alle
Men også i den medisinske verden skaper stadig nye studier og nye behandlingsmetoder forvirring. I USA bestemte politikerne seg for å gjøre noe med problemet. Kongressen har derfor oppnevnt et panel med uavhengige eksperter som skal avgjøre hva som skal være den beste behandlingen –for hele befolkningen.
Panelet har fått navnet U.S. Preventive Service Task Force (USPSTF), og medlemmene skal gå gjennom alle studier for å finne ut hva som er best egnet til å behandle sykdom. Deretter skal gå ut og anbefale den metoden som de mener har beste dokumentert effekt.

Kalsium/ikke kalsium
Vitamin D og kalsium mot benskjørhet hos kvinner som er ferdig med overgangsalderen, har lenge vært en slik såkalt vedtatt sannhet i det medisinske fagmiljøet.
Men så kom ekspertene i USPSTF i februar i år med sin anbefaling. De mener nå at leger ikke skal gi vitamin D eller kalsium til kvinner som er ferdig med overgangsalderen. Ved å gå gjennom mesteparten av studier på dette området, kom de fram til et resultat som overbeviste dem om at tilskuddet likevel ikke bygger nok benmasse til å redusere risikoen for brudd. I tillegg fant de at tilskudd av vitamin D medfører en liten risiko for nyresten. Mens for mye kalsium i blodet kan føre til både hjerte- og nyresvikt.
Bivirkninger
Nestlederen for panelet, dr Michael LeFevre, mener det skyldes en kulturell misforståelse når enkelte hevder at medikamenter og medisinsk behandling bare har en positiv effekt på pasienter.
– All medisinsk behandling innebærer også en risiko, og kan gi alvorlige bivirkninger. Nå vil vi i stedet stille flere spørsmål om hva som er best for pasienten når vi vurderer en behandlingsmetode. Hvor stor er risikoen, og vil den positive effekten veie opp for en smertefull behandling som kan gir mange bivirkninger?
Han tror forslaget vil få mange og spesielt eldre pasienter,
til å bli engstelig. Studier viser at eldre i USA ønsker å ta opptil flere årlige kreftundersøkelser. Får de ikke lenger dette tilbudet, frykter mange for at det kan øke risikoen for sykdom.
Ikke bindende
Rådene fra panelet er ikke bindende. Flere pasientgrupper i USA er nå kritisk til panelets mandat, og ønsker mer individuelle anbefalinger. Den amerikanske kreftforeningen stiller seg også kritisk til at panelet bl a anbefaler færre mammografiundersøkelser. Flere undersøkelser gir større mulighet for å finne farlige svulster, mener kreftforeningen. Mens panelet svarer at foreningen heller bør informere sine medlemmer om antall såkalte falske positive funn ved mammografi; noe som igjen kan føre til enda flere unødvendige tester og svært bekymrede pasienter.
Skal/skal ikke
Alt dette skaper mye forvirring, men dr LeFevre sier at det likevel ikke må føre til at leger slutter å diskutere ulemper og fordeler ved en ny behandlingsmetode med sine pasienter. – Legen og pasienten i samråd må bli enige om det er verdt å starte en slik behandling. Men en slik avgjørelse bør ikke tas før de har snakket om både risikoen og alle bivirkningene som også følger med.
I USA har det nå kommet nye anbefalinger for blant annet hormonbehandling og PSA-tester.
Hormonbehandling (HRT)
Før: Østrogen/progestin-behandling i overgangsalderen kan gi lavere risiko for å utvikle hjertesykdom og forhindre benskjørhet.
Nå: HRT kan øke risikoen for brystkreft. Tilskudd beskytter ikke mot hjertesykdom, i motsetning hva tidligere studier har vist.
PSA-tester er unødvendige
Før: Alle menn over 50 år bør ta regelmessige blodprøver for å sjekke for prostatakreft (USA).
Nå: Slike blodprøver kan oppdage svulster som er helt ufarlige, men som kan lede til risikofylte behandlinger.
Mange svulster er saktevoksende og trenger ikke å bli fjernet – til tross for at de er ondartede.
Før: Vitamin D og kalsium kan forhindre benskjørhet og forhindre brudd hos kvinner etter overgangsalderen.
Nå: Tilskuddet kan kanskje bremse bentap, men anbefalt dose er antakelig ikke stor nok til bremse brudd. Mye kalsium kan øke risikoen for hjertesykdom.
(Kilde: TIME/Annals of Internal Medicine, JAMA Internal Medicine)
Kolesterolverdiene ser ut for å stige om vinteren, for så å synke til normalt nivå om sommeren.
Tekst: Ellenor Mathisen
Vinteren er ikke bare lang og kald på den nordlige halvkule; den ser ut til å påvirke kolesterolnivået på en ugunstig måte.
Men da brasilianske forskere ved State University of Campinas fulgte kolesterolnivået til cirka 230 000 personer over en periode på to år, ble de overrasket. Selv i solfylte Brasil så de at kolesterolnivået hos brasilianerne steg kraftig på vinteren, for så å normalisere seg igjen om sommeren. Deltakerne i studien var kvinner og menn, og de fleste var mellom 50 og 60 år. Studien er publisert i tidsskriftet American College of Cardiology.
Fikk statiner
Resultatet av studien viste at LDL økte med gjennomsnittlig 0,15 mmol/L, mens HDL økte med cirka 0,1 mmol/L gjennom vinteren.
Forskerne så at både det gode kolesterolet (HDL) og det dårlige (LDL) endrer seg gjennom de ulike årstidene – for så å synke til normalt nivå om sommeren. De er derfor spesielt bekymret for hva dette kan ha å si for kolesterolnivået hos mennesker som bor i Nord-Europa og i NordAmerika hvor vinteren er både lengre og kaldere enn i Brasil.
Hjerteproblemer
Her hjemme er vinteren kjent som høysesong for hjerteinfarkt. Men denne studien viser at folk som bor i varmere land, også er mer utsatt for hjertesykdom om vinteren. Dette førte til at over 18 000 av deltakerne ble satt på statiner. Årsaken til stigningen i kolesterolnivået kan skyldes ulike ting, som f eks mindre trening og større inntak av fettrik mat. Men det er også færre soltimer om vinteren, noe som fører til mindre vitamin D.
Må sjekke
De brasilianske forskerne sier at de er mest bekymret for at den årlige kolesterolsjekken ikke fanger opp denne endringen – slik at bruken av statiner forblir den samme hele året.
De mener at leger derfor må sjekke kolesterolnivået til sine pasienter flere ganger i året for å hindre at de fortsetter å ta medisiner til tross for at de ikke trenger det. For å hindre at kolesterolet stiger kraftig om vinteren, er rådet å trene mer, sørge for sunnere mat og å få mer sol. Siden det siste ikke er mulig på våre breddegrader av helt naturlige årsaker, kan økt inntak av vitamin D være en god løsning. Mange studier har vist at vitamin D kan forbedre forholdet mellom det gode og det dårlige kolesterolet. Totalt kan disse rådene være gode for både kropp og sjel – og ikke minst – for hjertet.
– Også kjent her
Kjetil Retterstøl ved Institutt for medisinske basalfag, UiO, sier i en kommentar at studien er interessant.
– Vi kjenner til slike endringer i kolesterolnivået også her i landet. Jeg mener slike sesongvariasjoner er omtrent den samme her, selv om klimaforskjellene og soleksponeringen i Norge er større enn i Brasil. Men forklaringene kan være for liten fysisk aktivitet om for mye fet mat i vinterhalvåret, påpeker han.


Nycomed

til et enda friskere Norge




Gjennom 138 år har Nycomed bidratt til å gjøre Norge friskere. Det fortsetter vi med, under navnet Takeda Nycomed.
Navnet kommer fra vår nye eier. Takeda er et globalt farmasøytisk selskap som tilfører er vi en del av et forskningsmiljø i verdensklasse. Vi tilbyr nå det norske folk et enda bredere utvalg av legemidler og helsefremmende produkter.
Takeda Nycomed vil fortsette å være en aktiv medspiller for norske farmasøyter og andre
www.takedanycomed.no
TIPS: ABONNER NYHETSBREVPÅ FOR Å HOLDE DEG OPPDATERT OM NYE KURS WWW.APOKUS.NO



Apotekenes kompetanse- og utviklingssenteret, Apokus, gjør det lettere å oppdatere fagkunnskap for ansatte i apotek. Fire ganger i året kommer det ut nye kurs, og neste


Eldre og legemidler



KURSKODE: LU101 & LU102 Legemiddelbehandling av astma og KOLS del 1 & 2

KURSKODE: SM102 Smertebehandling ved kreft

Håvard Bjørnstad er advokat og utfører oppdrag for Farmasiforbundet. havard.bjornstad@codex.no
Nyansettelser
kan være en stor utfordring når man på den ene siden skal ha dekket inn et behov for arbeidskraft så raskt som mulig, mens man samtidig skal ansette rett person.
Feilansettelser kan koste bedriften dyrt, og det vil i de fleste tilfeller lønne seg å gjøre grundige undersøkelser av kandidatene før man treffer sitt valg. Informasjon om de enkelte kandidatene kan tenkes innhentet fra flere hold, men hovedvekten vil vanligvis kartlegges gjennom spørsmål direkte til kandidaten.
I tillegg til spørsmål om kandidatens kompetanse og faglige kvalifikasjoner, samt innstilling og motivasjon m.m., kan arbeidsgiver ut fra et bedriftsøkonomisk perspektiv også ønske å kartlegge kandidatens helse og sosiale forhold, for å sikre seg at arbeidstakeren man velger, er i stand til å yte 100 %.
Spørsmålstilling knyttet til slike forhold er imidlertid underlagt strenge lovpålagte begrensninger, herunder i arbeidsmiljøloven og likestillingsloven, som forbyr spørsmål om - og innhenting av - en rekke opplysninger. Det kan således være vanskelig, og samtidig viktig, å unngå å trå feil her.
Dette kan arbeidsgiver spørre om:
Spørsmål og innhenting av opplysninger i ansettelsesprosessen bør som det klare utgangspunkt være relatert til arbeidsforholdet, og belyse kandidatens egnethet og kvalifikasjoner for stillingen. Relevante temaer vil typisk være, faglig kompetanse, samarbeidsevner, lederegenskaper, pålitelighet, produktivitet og engasjement m.m.
I tillegg vil det ofte være kunne være relevant å kartlegge kandidatens humør og innstilling, samt mennesketype og
liknende som kan være avgjørende for om personen passer inn i arbeidsmiljøet i bedriften.
Dette kan du ikke spørre om:
De begrensninger som gjelder for de spørsmål arbeidsgiver kan stille, knytter seg i all hovedsak til forbud mot å diskriminere visse arbeidstakere. I medhold av arbeidsmiljøloven kapitel 13 vil det således ikke være anledning til å stille spørsmål om: Seksuell orientering, etnisitet, nasjonal opprinnelse, avstamming, religion/ livssyn.
Med visse unntak kan arbeidsgiver heller ikke stille spørsmål om kandidatens politiske syn, samlivsform eller medlemskap i arbeidstakerorganisasjon.
Videre følger det av arbeidsmiljøloven § 9-3, at det ikke er lov til å stille spørsmål knyttet til andre helseopplysninger enn det som er nødvendige for å utføre de arbeidsoppgavene som er relevant for stillingen.
For øvrig nedfeller likestillingsloven § 4 tredje ledd forbud mot spørsmål om graviditet, adopsjon eller familieplanlegging. Denne bestemmelsen gjelder uavhengig av kandidatens kjønn.
Grensetilfeller
Enkelte av ovennevnte forbud er relativt klare, og levner liten tvil om hva som er lovlige og ulovlige spørsmål. Det er likevel ikke til å komme unna at det finnes en del grensetilfeller.
Først og fremst vil dette kunne gjelde spørsmål om
kandidatens helse går. Slike spørsmål vil det være anledning til å stille i den grad de er relevant for de konkrete arbeidsoppgavene som skal utføres. Mer generelle spørsmål knyttet til omfanget av tidligere sykefravær, vil som utgangspunkt sannsynligvis ligge utenfor det arbeidsgiver kan spørre om. Her vil det likevel kunne tenkes at dette spørsmålet vil ha direkte relevans for utførselen av enkelte arbeidsoppgaver og således likevel må tillates. Dette vil for eksempel kunne være dersom stillingen krever en regelmessig og omfattende personlig tilstedeværelse, som ikke vil være forenlig med stort sykefravær.
Når det gjelder spørsmål om kandidatens politiske syn og eventuelt medlemsskap i arbeidstakerorganisasjon, vil dette som den store hovedregel ikke være tillatt.
Dersom dette er begrunnet i stillingens karakter, eller det inngår i formålet for vedkommende virksomhet å fremme bestemte politiske syn, og arbeidstakerens stilling vil være av betydning for gjennomføringen av formålet, kan slike spørsmål likevel være tillatt. Tilsvarende gjelder for opplysninger om søkerens samlivsform. En forutsetning for at arbeidsgiver skal kunne stille slike spørsmål er i alle tilfelle at dette på forhånd er angitt i stillingsutlysningen.
Konsekvensen av å stille ulovlige spørsmål
Dersom arbeidsgiver stiller spørsmål eller innhentet opplysninger i strid med ovennevnte vil dette på bakgrunn av bevisbyrde- og presumpsjonsreglene i arbeidsmiljøloven § 13-8 og likestillingsloven § 16, vil dette ofte bli å anse som diskriminering i strid med loven.
For tilfelle at slik diskriminering foreligger, vil arbeidsgiver være erstatningsansvarlig overfor den som har blitt diskriminert etter arbeidsmiljøloven § 13-9 og likestillingsloven § 17.
I denne spalten forsøker vi å svare på spørsmål som gjelder jobb og arbeidsmiljø. Ikke alle spørsmål kan man finne svar på ved hjelp av lovverket, men vi forsøker ved vår rådgivning å få frem hva man i slike situasjoner kan og bør gjøre, og hva vi mener er rett.

Floradix Formula er et flytende magnesiumpreparat uten vitaminer for maksimum opptagelse i organismen med sine lettfordøyelige varianter av magnesiumforbindelser. Her får man full utnyttelse uten å måtte ta med tapsvurderingen ved inntak i tablett/kapsel form. Oppløst i fruktjuicer og urter kan det lett taes opp i kroppen, samtidig som smak og virkning er god, velsmakende og lett å svelge. Les mer om magnesium på våre web sider www.naturimport.no
•Magnesium fremmer redusert tretthet og slapphet
•Magnesium fremmer opprettholdelsen av normale ben
•Magnesium fremmer et normalt funksjonerende nervesystem



Øst:
Vi klarte det!
Ved hjelp av yrkesstolthet, samarbeid og ønske om å være synlige gjorde vi alle søndag 17. mars til en suksess. Det var så godt å dele Apotekteknikerdagen 2013 med 150 medlemmer fra Region øst!



På BI Nydalen ble dagen fylt med mye latter, alvor og tanker om fremtiden. Ledelsen i Farmasiforbundet hadde sammen med Apotekforeningen mye spennende å fortelle om veien fremover for apotekteknikerne.
Vi håper dere alle har svart på spørreundersøkelsen angående fusjon, eller som vår redaktør Vetle så riktig sier det - ”samgående”. Les hans innlegg på farmasiforbundet.no under «Meninger». Her finner du også mange andre betraktninger om nåtid og fremtid. Kanskje akkurat du er en blogger? Kast deg ut i det, del dine meninger!
Mandag 22. april blir det medlemsmøte for alle som jobber i Østfold. Her arrangerer flotte medlemmer en kveld med middag og meninger. Her møter du også sekretariatsleder Arve Sigmundstad. Kvelden starter kl 18.30 på Quality hotell Sarpsborg. Meld deg på og få med deg dine arbeidskamerater. Invitasjon er sendt ditt apotek.
6. og 7. september 2013 arrangerer Region øst tillitsvalgtsamling og årsmøte. I år kaster vi loss og legger møtet til Color Lines Kiel ferje. Hold av helgen og bli med på spennende møtedager. Har din arbeidsplass ingen tillitsvalgt? Da kan jo du kaste deg ut i det!
Nyt våren, både på jobb og hjemme - husk at akkurat DU utgjør forskjellen!
Torhild S. Sauro
Leder, Region øst
Sør:
Vi i Region sør er i gang med «signingsferd» - vi har vært på mange apotek til nå, og vi kommer til å besøke flere. Vi har fått mange flotte tilbakemeldinger fra våre medlemmer og de synes det er helt topp at vi er på besøk hos dem.



Vi er ellers i gang med planlegging av årsmøte/ tillitsvalgtsamling som skal være i september, og vi håper vi ser flest mulig av våre flotte tillitsvalgte på dette møtet. I tillegg har vi våre styremøter, og det er mye nytt for oss tre i styret.
Etter å ha vært på besøk rundt omkring på flere apotek, ser jeg at det er flere av apotekene som ikke har tillitsvalgt. Jeg ber alle apotekteknikere som er uten tillitsvalgt om å velge en tillitsvalgt for teknikere på apoteket. Det er kjempeviktig med en tillitsvalgt på hvert apotek, uavhengig av hvor mange ansatte dere er. Det er ikke farlig å være tillitsvalgt, som tillitsvalgt har du mange muligheter, du kan dra på tillitsvalgtkurs og du blir tatt godt vare på av Farmasiforbundet, så ikke vær redd for å bli tillitsvalgt. En gang må være første gangen for alle og hver og en av dere kan mye mer enn det dere tror!
Vi vil prøve å lage gode møteplasser for medlemmene i Region sør. Bruk de sosiale mediene vi er på, vi har egen Facebook-gruppe som er kun for medlemmer i Region sør, jeg ber alle som er på Facebook om å bli medlem i vår Facebook-gruppe, som heter Region Sør Farmasiforbundet.
Ikke vær redd for å ta kontakt med oss i styret hvis det er noe vi kan hjelpe deg med, vi gjør så godt vi kan og setter stor pris på tilbakemeldinger fra dere. Vi ønsker flere innspill på hva dere som medlemmer ønsker at vi skal jobbe.Vi er her for dere!
Sairan Palani
Leder, Region sør
Vest:
Det går ikke an å skrive i bladet uten å nevne Apotekteknikerdagen. Arrangørene kan være stolte av et flott sammensatt program, der apotekteknikeres yrkesstolthet ble framhevet.



Styret i Region vest reiste inspirert hjem, klare til å ta fatt med arbeidet i egen region. Vi tror denne typen arrangement blir viktige for Farmasiforbundet også i fremtiden.
I skrivende stund ser vi fram til et hyggelig møte i Stavanger med medlemmer fra Rogaland sør. I mai tar vi turen til Førde, og i juni skal vi ha medlemsmøte i Bergen. På møtene blir det årets lønnsoppgjør og fusjonsforberedelsene som står på programmet. Begge disse temaene er høyaktuelle og medlemmene skal få aktuell informasjon fra oss, og får komme med meninger og innspill.
Vi møter jo alltid vårens oppgjør med spenning og forventning. I år har vi sågar forberedt oss på kamp ved å la utvalgte tillitsvalgte ta konfliktberedskapskurs.
Farmasiforbundet i fusjon med Parat eller Delta vil medføre svært mange endringer i forbundets rolle. Det er viktig at vi tar dette innover oss og innstiller oss på å møte de endringene som kommer. Jeg er overbevist om at ved å fusjonere får medlemmene tilgang på fagforeningstjenester på et mye høyere nivå enn det vi har nå.
Farmasiforbundet vil i tillegg bli en yrkesorganisasjon der etaten og faget kan få enda større fokus.
Wenche Haakedal Leder, Region vest
For en utrolig inspirende vinter det har vært!
I mars arrangerte vi tillitsvalgtsamling og årsmøte på Rica Nidelv i Trondheim, det ble ei super helg med engasjerte tillitsvalgte fra Sunnmøre i vest til Trøndelag i nord. Ledelsen stilte med forbundsleder, nestleder og sekreteriatsleder. Fantastisk at alle kunne komme og at deltakerne fikk ”fersk” informasjon om alt fra streikeberedskap til fusjonsplaner.



Før påske var vi i styret i Region midt invitert til Apotekteknikerdagen i Nydalen, vi er mektig imponerte over opplegget og er absolutt fristet til å arrangere en slik dag også her i vår region med tiden. Var vi noen gang i tvil om hvem som er de viktigste i apoteket, så er vi ikke det lengre! Ikke dumt å få et påfyll av yrkesstolthet. Jobben som gjøres av oss apotekteknikere i det ganske land er fenomenal. Vi må bare stå på videre! Still krav til arbeidsgiveren din, la apotekeren din få vite hvilken viktig jobb du gjør på din arbeidsplass hver dag. Vi er altfor beskjedne og har all grunn til å rette oss opp i ryggen å være stolt av yrket vårt!
Det er en kjensgjerning at mange av medlemmene i Farmasiforbundet nærmer seg pensjonsalder, i en travel apotekhverdag er det lett å glemme at vi som yrkesgruppe trenger nyrekruttering for å overleve. Tenk litt på hvordan du ordlegger deg neste gang du er i møte med en praksiselev. Vær ærlig om arbeidsforholdene og mulighetene for arbeid der du bor, men husk å fortelle hvor stolt du er av ditt yrke og viktigheten av din kompetanse. Vi må aldri glemme at vi er en stor del av ”apotek-skuta”!
I høst ble det valgt nytt styre i Region midt. Jeg benytter anledningen til å takke for tilliten. Vi er absolutt ydmyke for rollen, vi gleder oss til å utføre den og mener vi er godt i gang. Med en god porsjon pågangsmot, arbeidsvilje og erfaringen dette styret sitter inne med, er jeg sikker på at målet om å nå flere tillitsvalgte og medlemmer kan oppnås. Fra og med i høst planlegger vi, som Region sør, en ”signingsferd”. Vi ønsker å oppsøke de tillitsvalgte ute i apotekene og arrangere flere medlemsmøter lokalt. Ta gjerne kontakt om du har forslag til møtesteder eller om dere vil ha besøk!
”Å være medlem i en fagforening betyr å være med i et nettverk av mennesker som jobber mot felles mål.” Dette er bare en av mange fordeler av å være organisert.
Jannicke Koppen,
1. vara Region midt, apotektekniker og stolt av det!
Tiden flyr, vi nærmer oss vårens tillitsvalgtsamling og årsmøte i nord, og det jobbes med den siste ”finpussen” til arrangementet.
Samtidlig ønsker vi i styret å få et økt fokus i vår region på å få flere til å utdanne seg til apotekteknikere.



Det finnes et tilbud der ute for de som har jobbet i apotek en stund og har masse erfaring men ikke den formelle utdannelsen. Et viktig poeng er også at som fagutdannet apotektekniker vil det generere høyere lønn.
I nord har vi en apotekteknikerlinje på Breivika videregående skole i Tromsø, Opus i Bodø har gitt mulighet til å ta eksamen som apotektekniker og nylig ble det kjent at Hadsel vgs på Stokmarknes har opprettet en linje som blant annet er en apotekteknikerlinje. Det er veldig gledelig at vi nå da har fått en viss spredning i tilbudet til de som vil ønsker å utdanne seg til apotekteknikere.
Nå er det sånn da at avstandene er lange i vår del av landet, og ikke alle har anledning til å reise vekk for å gå på skole, men kan tenke seg muligheten til å kunne lese på egen hånd og gå opp til eksamen som privatist. Men det synes å være en litt tungrodd vei for å gå opp som privatist for de som ønsker det. Vi har sett litt nærmere på dette ved å kontakte Nordland, Troms og Finnmark fylkeskommune for å vite hvem man kan kontakte og hva som kreves for å gå opp til eksamen.
I Nordland-området er det slik at det eksisterer ingen krav for å få tatt privatisteksamen. Privatisteksamen i alle fag - også apotektekniker - arrangeres to ganger per år. Oppmeldingsfristene er ca medio september og i begynnelsen av februar. Dette annonseres forøvrig i alle fylkets aviser, og det ligger oppmeldingsskjema osv på deres hjemmeside. Privatister som skal avlegge muntlig, muntlig-praktisk eller praktisk eksamen, får opplyst eksamensdato direkte fra skolen. De fleste vil bli lagt til mai måned. Nordland fylke bruker for øvrig ikke «privatistWeb».
Du melder deg altså opp til den skolen der du ønsker å avlegge eksamen ved å kontakte dem direkte. Dersom du trenger mer informasjon og rettledning, ta kontakt med rådgiver eller eksamensleder på en videregående skole.
Troms fylkeskommune opplyser om at all oppmelding til privatisteksamen skjer på www.privatistweb.no Dersom det gjelder ansatte over 23 år med 5 år med allsidig praksis inkludert skolegang kan de gå opp til privatisteksamen i APO3102 som er skriftlig tverrfaglig eksamen som må tas før den praktiske fagprøven. Dersom ikke kravene er oppfylt må de ta samme eksamener som elever i VGS med eksamen på alle trinn (VG 1,VG2 og VG3)
Finnmark fylkeskommune opplyser om at for de som er over 25 år og/eller ikke har videregående utdanning får man en vurdering av realkompetansen, og plan over hva slags fag de mangler for å få fullført en utdanning ved å ta kontakt med godkjenningssentralen i Alta. De videregående skolene arrangerer kurs og opplæring for voksne med et tilbud som er tilpassa hvert enkelt behov. Privatisteksamen i alle fag blir avviklet to ganger i året på alle de videregående skolene i fylket som annonseres i avisene og man melder seg opp via www.privatistweb.no Den siste avsluttende eksamen for apotekteknikk er praktisk, og avvikles i samarbeid med Troms fylkeskommune i Tromsø.
Når det gjelder vurderingsrettledning for privatister er det slik at når du går opp til eksamen som privatist, er du sjøl ansvarlig for å skaffe deg informasjon om fagets læreplaner og om hva som kreves for å oppnå ulike karakterer i faget.
Håper at dette kan være en liten ”veiviser” for de av dere som har lyst til å få en formell utdannelse som apotektekniker. Vi ønsker at vår yrkesgruppe også i fremtiden skal ha en naturlig plass i apotek og andre steder i helsevesenet hvor apotekteknikere også jobber i dag. Det dukker stadig opp nye/andre tilbud så følg med. Kanskje det er rett i nærheten av deg.
Åse Helen Andersen
Leder, Region nord
Farmasiforbundet ønsker følgende nye medlemmer velkommen:
Amin SadafBoots apotek Grorud
Anne RunnaneApotek 1 Løven Haugesund
Anne Grethe TømmerholenApotek 1 Stange
Anne Ohma TimeVitusapotek Symra
Aqsa Riaz AhmadApotek 1 Nittedal
Camilla BallestadApotek 1 Handelsparken Lyngdal
Eva Nygård IbsenVitusapotek Moelv
Hanne Sæther BreivoldApotek 1 City Syd
Heidi AskheimApotek 1 Løven Kristiansand
Heidi Cathrine CarlsenBoots apotek Rygge Storsenter
Heidi Rørvik KjøsnesBoots apotek Nordre
Hilde Merete KvammenApotek 1 Lonevåg
Ingrid Terning VestlySjukehusapoteket i Haugesund
Kristine GjerstadApotek 1 Løven Haugesund
Latifa AitannourBoots apotek Grorud
Line KjørkleivApotek 1 Handelsparken Lyngdal
Liv Annbjørg Bjørnevik
Marcin Wojciech TuszynskiDitt apotek Sørumsand
Mette Trine LillebostadVitusapotek Aker Brygge
Mosiej Blonska SylwiaApotek 1 Knarvik
Nina Urdal CirotzkiDitt Apotek Luster
Reidun RøneidDitt Apotek Luster
Rita JølstadVitusapotek Nesodden
Shazadi BibiVitusapotek Jernbanetorget
Signe HagenSykehusapoteket Kristiansand
Sujatha KamalanathanVitusapotek Furuset
Vjosa KallabaApotek 1 Bjørnen
Linn Ørnvall
Mona Lindahl
Elevmedlemmer:
Diana Alikovna Mukajeva
Nozad Salimi
Ragna Myksvoll
Tonje Karoline Nygård

Visste du at Farmasiforbundet også er på Facebook? Her kan du delta i debatter, se bilder fra forbundets aktiviteter og komme i kontakt med andre apotekteknikere.

Du finner oss her: www.facebook.com/farmasiforbundet
Har du smarttelefon med QR-scanner?
Scan denne, og du kommer rett til Farmasiforbundets side.

Denne vinteren har gått utrolig fort med mange oppgaver for Farmasiforbundet.
Det startet med representantskapsmøtet i november, da det ble bestemt at vi skulle finne ut om det var lurt å fusjonere med et annet forbund. På Gardemoen i februar fikk alle regionene og de hovedtillitsvalgte en mer detaljert informasjon om de forbundene det var aktuelt å fusjonere med. Der ble det satt ned en gruppe som skulle være et forhandlingsutvalg som jeg ble en del av. Dette har vært en enormt spennende jobb og vi har hatt konstruktive møter med både Delta og Parat som er de forbundene vi eventuelt vil fusjonere med.
«Personlig tror jeg det vil være best for oss å fusjonere med et større forbund»
Dette er store organisasjoner med stor tyngde og masse ansatte. Ser nå hvor små vi er i Farmasiforbundet, men samtidig er det litt godt å være liten også. Begge organisasjonene har store ressurser og kan tilby hjelp både når det gjelder tariff, konflikter på arbeidsplassen, arbeidsrett og opplæring av tillitsvalgte. Organisasjonene er litt forskjellig oppbygd, men begge er interessert i å ha oss med videre. Heldigvis får vi uansett beholde vårt eget navn, slik at Farmasiforbundet vil bestå. Jeg ser også at vi får en del fordeler vi ikke klarer å få hvis vi står alene. Personlig tror jeg det vil være best for oss som forbund å fusjonere med et større forbund, men først må vi forhandle ferdig og se på de eventuelle gevinstene vi får av en fusjon,
vi er uansett nødt til å gjøre en grundig jobb her. Er optimist og tror vi vil komme frem til en løsning som de fleste av oss vil gå for. Vi blir færre medlemmer og aldersgruppa vår blir høyere og høyere, nå er vel snittalderen på apotekteknikerne godt over 50 år. Dette er en litt bekymringsverdig utvikling, og vi må virkelig satse på rekruttering til yrket vårt. Dette må vi alle være bevisst på og muligens bør utdanningen endres også. Dette er saker det jobbes godt med både blant ledelsen i kjeder/foretak og i Farmasiforbundet.
En annen sak som opptar meg for tiden er pensjonsordningen i POA (Pensjonsordningen for apotekvirksomhet). At pensjonsordningene blir endret er det ingen tvil om, men hvilken form den vi vil få er ennå usikkert. Det foregår et utredningsarbeid hvor både arbeidsgivere og arbeidstakersiden er med for å få mer kunnskap om POA. Dette har vært interessant og lærerikt, men også vanskelig. Jo mer man hører om pensjon jo mer lurer man på. Men er det noe som er sikkert så er det at vel at det vil lønne seg å jobbe mest mulig og lengst mulig! Det er ennå en samling igjen og det skal være komme en sluttrapport før sommeren. POA har i likhet med en del andre pensjonsordninger fått dårligere økonomi enn før, selv om fjoråret ga et ganske bra resultat. Årsakene til at økonomien er blitt dårligere er flere: antall yrkesaktive pr. pensjonist går stadig nedover, fra 3.9 i

1969 til 2.6 i 2007. I tillegg har det vært investert i fond etc som har gitt dårligere avkastning enn forventet. Levealderen er blitt høyere, flere går av med uføretrygd og APF enn forventet. Likeså er det mange som har sluttet i apotekbransjen og gått over i andre yrker. De har hatt pensjonsordning i POA før og er derfor fortsatt omfattet av ordningen. Derfor er det lett å forstå at det kan være et økonomisk dilemma, men jeg håper vi likevel kan fortsette å ha ordningen da den gir trygghet for medlemmene. POA-ordningen er lovpålagt og det er ikke bare å si den opp.
Da er det bare å se fremover mot våren med masse spennende oppgaver foran oss – fusjon, pensjonsordning og ikke minst lønnsforhandlinger!

Tlf. 800 800 30 • infonorge@takeda.com www.nycomed.no • www.takedanycomed.no Et reseptfritt legemiddel for korttidsbehandling ved reflukssymptomer hos voksne. Inneholder 20 mg pantoprazol. Les pakningsvedlegget nøye før bruk.
Foto: www.colourbox.com








På apoteket jobber han mest med logistikk. Hjemme ser han på interiørprogrammer og driver med trening. Møt Aliou Diawara (53).
Tekst og foto: Vetle Daler
Hva er det beste med å jobbe i apotek?
At det er mye variasjon, og at jeg har spennende oppgaver innen blant annet logistikk og ASL (apotekstyrt legemiddellager).
Hva gjør deg til en god apotektekniker?
At jeg holder meg oppdatert, og ikke minst mine gode kollegaer.
Ditt drømmeyrke utenom å være apotektekniker?
Aktivitør. Hjelpe ungdom eller eldre som har problemer med å bevege seg.
Hva gjør en apoteker til en god leder?
At hun/han sørger for at alle ansatte føler seg trygge, og at hun/han fordeler oppgave og ansvarsomsåder riktig. Og at ansatte får tid og mulighet til å utvikle og fordype seg.
Hvem vil du helst stå fast i en heis sammen med?
En lekker blondine.
Hva spiser du til frokost?
Det er veldig enkelt – frokostblanding og en kopp te.
Hvilken TV-serie følger du med på?
Decor – en interiørserie på en fransk kanal.
Hva slags bil kjører du?
Jeg har ikke bil.
Navn: Aliou Diawara
Alder: 53


Bosted: Hauketo i Oslo
Familie: Gift, to barn
Arbeidssted: Sykehusapoteket Ullevål, Oslo
Stilling/ansvarsområde: Apotektekniker
Apotektekniker siden: 1998
Tillitsverv: Nei
Interesser: Sport og trening
Hvilken bil ville du helst kjøre?
Peugeot.
Hvis du var politiker, hva ville du først gjøre noe med?
Helse og eldreomsorg.
Hvorfor er det viktig å være medlem i Farmasiforbundet?
Fordi Farmasiforbundet jobber for å styrke våre rettigheter, og fordi man får hjelp når trenger det. Jeg liker at forbundet jobber for våre verdier.
Hva har du på nattbordet?
Vekkerklokke, radio, briller og en bok.













































































































Symptomatisk behandling for uregelmessig halsbrann (opp til en gang i uken)




























Danner en sterk barriere på toppen av mageinnholdet som effektivt hindrer refluks å oppstå


Ta etter måltider og før du går til sengs. 10-20 ml doser.























3. 2. 1.


Symptomatisk behandling for refluks ved graviditet





Supplement til PPI- behandling, spesielt når symptomene forekommer etter måltid og når man ligger


(E 218 et E 216), sacchar. natric., natr. hydrox., aqua purif. q.s. Mintsmak. TYGGETABLETTER: Hver tyggetablett inneh.: Natr. algin. 250 mg, natr. hydrogenocarb. 133,5 mg, calc. carb. 80 mg, aspartam. 3,75 mg, mannitol., const. q.s. Peppermyntesmak. Indikasjoner: Mikstur og tyggetabletter: Behandling av symptomer på gastroøsofageal refluks, som sure oppstøt, halsbrann og fordøyelsesbesvær, f.eks. etter måltider eller under graviditet. Tyggetabletter: Behandling av symptomer relatert til refluksøsofagitt. Dosering: Mikstur: Voksne og barn 12 år: 10-20 ml etter måltider og ved sengetid (inntil 4 ganger daglig). Barn <12 år: Skal kun gis etter anvisning fra lege. Tyggetabletter: Voksne og barn 12 år: 2-4 tabletter etter måltider og ved sengetid (inntil 4 ganger daglig). Administrering: Oral bruk. Tyggetabletter: Skal tygges grundig før svelging. Kontraindikasjoner: Mikstur og tyggetabletter: Overfølsomhet for noen av innholdsstoffene. Mikstur: Overfølsomhet for esterforbindelser av hydroksybenzoater (parabener). Effekten kan være redusert ved svært lavt magesyrenivå. Hvis symptomene ikke bedres innen 7 dager, må klinisk status vurderes. Behandling av barn <12 år anbefales vanligvis ikke, bortsett fra etter anvisning fra lege. Hver dose på 10 ml mikstur eller 4 tabletter inneholder hhv. 141 mg (6,2 mmol) og 246 mg (10,6 mmol) natrium. Dette bør tas i betraktning ved saltkontrollert diett, f.eks. ved enkelte tilfeller av kongestiv hjertesvikt og nedsatt nyrefunksjon. Hver dose på 10 ml mikstur eller 4 tabletter inneholder hhv. 160 mg (1,6 mmol) og 320 mg (3,2 mmol) kalsiumkarbonat. Forsiktighet må derfor utvises ved hyperkalsemi, nefrokalsinose og tilbakevendende kalsiumholdig nyresten. Miksturen inneholder metyl- og propylparahydroksybenzoat som kan gi allergiske reaksjoner (mulig forsinkede). Tyggetablettene inneholder aspartam og skal ikke gis ved fenylketonuri. Interaksjoner: Antacidum og andre legemidler bør tas med minst 2 timers mellomrom, særlig H2-antihistaminer, tetrasykliner, digoksin, fluorokinoloner, jernsalter, ketokonazol, nevroleptika, tyroksin, penicillamin, betablokkere (atenolol, metoprolol, propanolol), glukokortikoider, klorokin og bisfosfonater. Bivirkninger: Svært sjeldne (<1/10 000), ukjent: Immunsystemet: Anafylaktiske eller anafylaktoide reaksjoner, overfølsomhetsreaksjoner som urticaria. Luftveier: Respiratoriske manifestasjoner som bronkospasme. Reseptgruppe: F Pakninger og priser: Mikstur: 150 ml (flaske) kr. 79.90. Tyggetabletter: 24 stk. (blister) kr. 79.90. 48 stk. (blister) kr. 144.90, 05/01/2013. Basert på preparatomtale for Galieve godkjent 23.11.2011 (mikstur) og 16.04.2012 (tyggetabletter). Reckitt Benckiser Healthcare (Scandinavia) A/S, +45 44 44 97 01
4623 685 5382 17592 9485 7 8 6594 8596
©Bulls
1. Hvor mange fylker er det i Norge?
2. Hvor mye er ett snes?
3. Hva heter forfatteren av bøkene om Harry Potter?
4. Hvilket år tok menneskene sine første skritt på månen?
5. Hva heter landbruksministeren?
6. Hvilket departement har Marit Arnstad ansvaret for?
7. Hva heter lederen i YS?
8. Hva heter lederen i LO?
9. I hvilken by ble Apotekteknikerdagen 2013 arrangert?
10. Hvilken dato er Sankthans?
Hele løsningen sendes innen 1. juni 2013
1. premie: 6 Flax-lodd 2. premie: 3 Flax-lodd
Navn: ...................................................................................................................
Adresse: ...............................................................................................................
Postnr. /Sted:. ......................................................................................................
Til: Farmasiforbundet, Hegdehaugsvn. 8, 0167 Oslo
Vinnere av kryssord i nr 1/2013:
1. premie 6 Flax-lodd: Anne Årnes 9019 Tromsø
2. premie 3 Flax-lodd: Elsa Helen Risa 4313 Sandnes
11. Hvem skrev romanen «Jonas»?
12. Hvilket land er også et kontinent?
13. Hvem har den mannlige hovedrollen i filmen «Hodejegerne»?
14. Hva heter NRKs kringkastingssjef?
15. Hvilket år ble kronprins Haakon født?
Vedum
Forleden måtte jeg på sykehus med eldstesønnen. Han hadde lekt akrobat i klasserommet i et friminutt, og gått skikkelig på trynet med nesa først –rett i gulvet. Resultatet ble en gråtende gutt med brukket nese, og dermed bar det til Ahus for operasjon.
På et av Norges mest utskjelte sykehus gikk alt på skinner – i nye, ryddige og rene omgivelser var vi omgitt av hyggelige, dyktige, grønnkledde helsearbeidere og følte oss trygge. Gutten ble traktert med DVD-film og flere av de populære «premiene» du vet, som er hovedgrunnen til at mange barn synes det er greit å gå til legen. Når anestesisykepleieren i tillegg disket opp med bedøvelseskrem, var det ikke så ille å få satt inn venflon, og takket være barnepedagogiske leger og sykepleiere, var gutten ved godt mot da han ble trillet avgårde til operasjonssalen. Der ventet et stort team av grønnkledde – alle dypt konsentrert om å hjelpe min sønn, med det som ikke engang var et alvorlig brudd.
Mens jeg satt på venterommet og filosoferte, fikk jeg nesten et stikk av dårlig samvittighet. For en service! For en omsorg! For et fantastisk helsevesen vi har! Vi er så heldigede fleste sjuåringer i verden er lysår unna å få den samme behandlingen. Det er på en måte både rørende og trist på samme tid.
Jeg vet at mange apotekteknikere opplever større og større press når det gjelder mersalg, bunnlinje og utenomprodukter. Men glem aldri at dere også er en del av det fantastiske
helsevesenet jeg skryter uhemmet av her. Dette har dere all grunn til å være stolte av!


Illustrasjon: Lena Asgeirsdottir
Farmasiforbundet gir deg trygghet – og hjelp når du trenger det. Det betyr at du kan kontakte oss hvis du har problemer eller spørsmål om ting som angår arbeidet ditt.
Private apotek


Boots
Gruppeleder Ingrid Katrine Løkke
Boots apotek Leütenhaven, Trondheim. Tlf.: 73 56 40 50 / 938 71 917 ingridkat66@hotmail.com
Apotek1
Gruppeleder Ann-Karin Berggren
Apotek 1 Løven, Sarpsborg. Tlf.: 90 09 76 15 ann-karin.berggren@apotek1.no

Vitusapotek
Gruppeleder Anita Sveum Nilsen
Vitusapotek Sandvika
Tlf. 67 55 19 00 / 97 06 01 41 anita_sveum_nilsen@hotmail.com
Dette hjelper lokale tillitsvalgte og hovedtillitsvalgte deg med:
• Spørsmål om tariffavtaler, herunder lønn, arbeidstid, permisjon og andre arbeidsforhold
• Spørsmål om tariff- og lønnsforhandlingene
• Spørsmål om konflikter med arbeidsgiver

Region nord
Åse Helen Andersen
Apotek 1 Hammerfest
Tlf. 92 81 58 29 ase.helen.andersen@ farmasiforbundet.no

Region midt
Sykehusapotek




Nord: Liv Norlid, Sykehusapoteket i Bodø Tlf.: 75 53 44 16 / 75 53 44 18 liv.norlid@nlsh.no
Midt: Liv Reisch, Sykehusapoteket i Trondheim. Tlf.: 73 86 42 00 / 92 41 09 32 liv.reisch@sykehusapoteket.no
Vest: Gunvald Iversen, Haukeland sykehusapotek
Tlf.: 98 83 46 55 gunvald.iversen@sav.no
Sør-Øst: Rita Riksfjord Antonsen Sykehusapoteket i Tønsberg
Tlf.: 97 09 29 80 rita.antonsen@farmasiforbundet.no
Inger Marie Arnesen
Boots apotek Stjørdal
Tlf. 92 63 50 12 inger.marie.arnesen@ farmasiforbundet.no
Dette hjelper regionslederne deg med:
• Informasjon om årsmøter, medlemsmøter og tillitsvalgtsamlinger

Region vest
Wenche Haakedal
Apotek 1 Arken, Bergen
Tlf: 99 56 61 22 we-haak@online.no







Arve Sigmundstad, sekretariatsleder
Tlf.: 97 77 20 29 arve.sigmundstad@farmasiforbundet.no
Berit Regland, fagsjef
Fag og utdanning
Tlf.: 22 99 26 66 / 91 12 46 52 berit.regland@farmasiforbundet.no
Anne Grete Morisbak, organisasjonssekretær
Medlemskap og kontingent
Tlf.: 22 99 26 71 anne.grete.morisbak@farmasiforbundet.no
Renate Messel Hegre, forhandlingssjef
Lønn, tariff og arbeidsrett
Tlf.: 22 99 26 64 / 92 60 73 51 renate.messel.hegre@farmasiforbundet.no
Unni Bakke, regnskapsfører
Kontingentinnbetaling og medlemskap
Tlf.: 93 04 34 39 unni.bakke@farmasiforbundet.no
Vetle Daler, redaktør og kommunikasjonsansvarlig
Tlf.: 22 99 26 61 / 92 40 53 91 vetle.daler@farmasiforbundet.no
Bente Trøen, sekretær
Tlf.: 22 99 26 60 office@farmasiforbundet.no

Region øst
Torhild S. Sauro
Sykehusapoteket Oslo, Radiumhospitalet
Tlf 22 13 42 42 / 91 15 85 00 torhild.s.sauro@farmasiforbundet.no

Dette hjelper sekretariatet deg med:
• Spørsmål om ditt medlemskap, kontingent eller andre ting som har med medlemsforholdet ditt å gjøre
• Spørsmål om pensjon
• Spørsmål eller kommentarer til informasjon du har fått fra Farmasiforbundet
• Spørsmål om kurs, opplæring og stipend
• Spørsmål om lønn/tariff og arbeidsrett
Region sør
Sairan Palani
Apotek 1 Sørlandssenteret
Tlf: 97 96 41 39
sairan.palani@farmasiforbundet.no
Forbundsleder:
Irene Hope Tlf.: 95 80 07 66 irene.hope@farmasiforbundet.no
Nestleder:
Bodil Røkke Havig, Sykehusapoteket ved Radiumhospitalet
Tlf.: 95 21 00 87 bodil.rokke.havig@farmasiforbundet.no
Styremedlemmer: Johnny Myrvold Vitusapotek Eidsvold Tlf.: 99 59 16 99. johnnymyrvold@hotmail.com
Åse Helen Andersen
Apotek 1 Hammerfest Tlf.: 92 81 58 29 ase.helen.andersen@farmasiforbundet.no
Ingrid Katrine Løkke, Boots apotek Leütenhaven, Trondheim. Tlf.: 93 87 19 17. ingridkat66@hotmail.com
Representant for de hovedtillitsvalgte: Ann Cicilie Tandberg, Vitusapotek Strømmen Tlf.: 90 56 95 61 cicilie.tandberg@gmail.com
Ansattes representant: Renate Messel Hegre Tlf.: 92 60 73 51 renate.messel.hegre@farmasiforbundet.no
Varamedlemmer:
Inger Marie Arnesen
Boots apotek Stjørdal Tlf.: 92 63 50 12 inger.marie.arnesen@farmasiforbundet.no
Heidi Gram
Apotek1 Xhibition, Bergen
Tlf.: 95 22 08 56 heidiegram@gmail.com
Se www.farmasiforbundet.no for mer info om forbundet.
Som medlem i Farmasiforbundet er du med i et nettverk av mennesker som jobber mot felles mål. Samtidig får du noe igjen som enkeltindivid i form av trygghet, kunnskap og innflytelse.
Dette gjør Farmasiforbundet for deg:
• Forhandler frem lønn og tariffavtaler
• Utgir medlemsbladet Farmasiliv
• Taler apotekteknikernes sak overfor myndighetene
• Arrangerer kurs for tillitsvalgte
• Driver rådgivning overfor medlemmer og tillitsvalgte
• Tilbyr gratis advokathjelp ved konflikter
• Tilbyr gunstige forsikringsordninger
Pensjonsordningen for apotekvirksomhet
Har du spørsmål om: pensjon, uførepensjon, boliglån, ta kontakt med Pensjonsordningen for apotekvirksomhet: telefon: 22 24 15 70 (08 – 15) eller e-post: apotek@spk.no. www.spk.no/apotekordningen
Postadresse: Postboks 5364 Majorstuen, 0304 Oslo
Besøksadresse: Slemdalsveien 37, Oslo
Skjema finner du på www.farmasiforbundet.no
Endring
Det er viktig for Farmasiforbundet å ha en så oppdatert informasjon om medlemmene våre som mulig. Det gjør at vi kan gi deg riktig informasjon. Samtidig får du tilgang til dine medlemsfordeler. I tillegg slipper vi å bruke ressurser på ettersending av post og lignende.
Husk å gi beskjed til oss ved:
• Navneendring
• Skifte av arbeidsplass
• Ny privat adresse
• Endring av medlemsstatus (Permisjon, sykemeldt etc.)
Utmelding
Utmelding av Farmasiforbundet skal skje skriftlig (brev, e-post eller faks).
Husk å gi din arbeidsgiver beskjed om stopp av trekk i kontingent ved utmelding.
Medlemskapet opphører fra den 1. i påfølgende måned etter at utmeldingen finner sted. Dette følger etter § 3 i våre vedtekter.
For endringer benytt:
Skjema på www.farmasiforbundet.no eller kontakt anne.grete.morisbak@farmasiforbundet.no
Telefon: 22 99 26 71 / faks: 22 20 13 01
Som medlem i Farmasiforbundet får du, gjennom YS, en rekke gunstige medlemsfordeler.
Gjensidige forsikring:
Spesialprisede forsikringer:
• YS Innbo
• YS Familieulykke
• YS Dødsfall
16-32 % YS-rabatt på andre forsikringer
Gjensidige bank:
• Lån til bolig fra 3,30 % nominell rente, og de beste sparerentene.
YS medlemskort med MasterCard:
• 3 % sparerente fra første krone
• Kredittreserve på inntil 75 000,-
• Kan brukes over alt
• Gebyrfrie varekjøp
• Gebyrfri nettbank
• Ingen årsavgift
YS sikkerhetsbutikk:
• Alle medlemmer i YS får 10 % rabatt på alle produktene i sikkerhetsbutikken.no
American Express:
• Som YS-medlem kan du opptjene EuroBonus Ekstrapoeng på alt du kjøper med SAS EuroBonus Classic American Express ® Card
Avis bilutleie:
• Rabatt på leiebiltjenester
Nordic Choice Hotels:
• Rabatt på hotellovernatting
Esso MasterCard for medlemmer av YS:
• Med Esso MasterCard får du billigere drivstoff, i tillegg får du rabatt når du vasker bilen.










Gudbrandsdal energi:
• Markedskraft Lavpris YS – kraft til innkjøpspris pluss et fastbeløp på kr 55,00 pr. mnd
Thon Hotels:
• Rabatt på overnatting, kurs, møter og konferanser.
Telenor:
• Lavere priser på en rekke privattjenester hos Telenor.















Nå har det kommet en ny serie produkter mot tørr munn: Xero-serien. Xero finnes foreløpig som harde sugetabletter og som en gel. Produktene stimulerer spyttproduksjonen, fukter og gir en behagelig følelse. Alle produktene inneholder i tillegg fluor. Tanken er at det skal finnes individuelle løsninger til alle døgnets timer, feks Xerodrops på dagen og Xerogel i løpet av natten. Produktene er utviklet i samarbeid med skandinaviske tannleger. Xero-serien er tilgjengelig på apotek og hos enkelte tannklinikker. Anbefal gjerne Xero neste gang!
Les mer om Xero-serien på www.xeroserien.no










ØKER SPYTTPRODUKSJONEN FUKTER


GIR STERKE TENNER